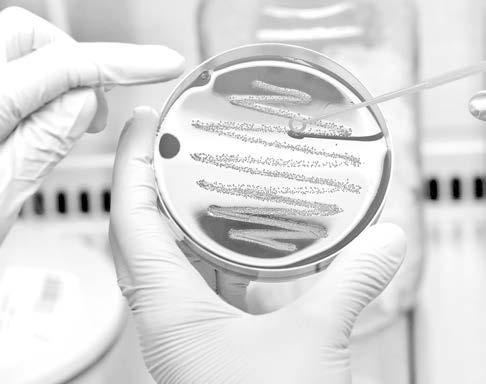

CON LA 4T, MUJERES LIBRES Y SEGURAS, SIEMPRE: CSH
Ante el pueblo de Nuevo León anunció el programa de ‘’Senderos Seguros’’

NULO TRABAJO DE GENARO AFECTARÁ A PRÓXIMO CANDIDATO

VERACRUZ MERECE SUBIR DE NIVEL: NAHLE

PROFECO INICIA OPERATIVO VACACIONAL


PRESENTAN COMITÉ DE CARNAVAL 2024

EXITOSO DESFILE DE PRIMAVERA
Más de tres mil participantes entre alumnos de nivel preescolar, docentes y padres de familia, hicieron de este recorrido una fiesta llena de colores y mucha alegría. TUXPAN
 Directora
Directora
Editorial: Lic. Julia Méndez Campos
| elheraldodetuxpan.com.mx | | JUEVES 21 DE MARZO DE 2024 | AÑO XX No 6099 $9.00 G R U P O E D I T O R I A L DE VERACRUZ NACIONAL · PAG 17 NACIONAL · PAG 2 TUXPAN · PAG 3 ESTADO · PAG 7
Director
General: Lic. Francisco Sánchez Macías
· PAG 4
· PAG 5
TUXPAN

»AGENCIAS
CIÉNEGA DE FLORES, NUEVO
LEÓN.- Garantizar la seguridad y libertad de las mujeres en México es prioritario en la construcción del segundo piso de la Transformación, señaló la candidata de la coalición “Sigamos Haciendo Historia” (Morena, PT y PVEM) a la Presidencia de la República, Claudia Sheinbaum Pardo, tras reunirse con simpatizantes de Ciénega de Flores, en el estado de Nuevo León.
“Vamos a hacer una campaña muy grande para protección de las mujeres, porque vamos a gobernar para todos y para todas, para niños, niñas, adultos mayores (...) Pero también vamos a gobernar para las mujeres, para que las mujeres se sientan libres y seguras siempre en nuestro país”, afirmó.
Por ello, anunció que llevará a los municipios con más incidencia de delitos contra las mujeres el programa de ‘’Senderos Seguros’’, que puso en marcha cuando fue Jefa de Gobierno de la Ciudad de México.
“Iluminamos la ciudad y les llamamos ‘Senderos para Mujeres Libres y Seguras’, porque si una niña puede caminar segura en la calle, todos podemos caminar seguros en la calle y lo vamos a echar a andar en los principales municipios del país


Con la 4T, mujeres libres y seguras, siempre: CSH
Ante el pueblo de Nuevo León anunció el programa de ‘’Senderos Seguros’’ para los municipios con más violencia en el país
con problemas con violencia contra las mujeres, los Senderos Seguros”, anunció.
Recordó que esta estrategia integral y de atención a las causas ya dejó resultados en la capital del país, donde logró disminuir a la mitad la incidencia de homicidios dolosos y en 60 por ciento los delitos de alto impacto.
“No solo demostramos que las mujeres podemos, sino que lo hicimos con una estrategia de atención a los jóvenes, con educación, con cultura, con deporte, pero también avanzando en la cero impunidad, que, si se comete un delito, que sea sancionado ese delito y disminuimos los feminicidios en 30 por cien-
AGENCIAS
XALAPA
Será el 27 de abril cuando se lleve a cabo el primer debate de los aspirantes a la gubernatura del estado de Veracruz, organizado por el Organismo Público Local Electoral (OPLE), informó el consejero Roberto López Pérez.
El integrante del Consejo General del OPLE dijo que la sede de este primer debate será Xalapa, en las instalaciones del Museo de Antropología a las 18 horas.
En la sesión extraordinaria de este miércoles mencionó que durante el desarrollo del Proceso Electoral 2023-2024 se llevarán a cabo dos debates políticos, a fin de que la ciudadanía conozca los planes y proyectos de quienes aspiran a gobernar el estado.
to en la ciudad”, recordó. Como parte de los proyectos regionales, Claudia Sheinbaum anunció apoyo para el municipio de Ciénega de Flores para la construcción de un distribuidor vial que mejore su conectividad.
“Ya vamos a ayudar al presidente municipal de Ciénega porque me dijeron que se requiere de un libramiento para poder llegar aquí a Ciénega”, adelantó.
Por su parte, Luis Orlando Quiroga Treviño, candidato a diputado federal por el Distrito 13, destacó la aceptación que tiene Claudia Sheinbaum entre los habitantes de su distrito, por lo que no dudó en que la transformación conti-
nuará desde la Presidencia de la República.
“En todos los municipios, cuando toco las puertas de los vecinos, siempre que menciono el nombre de la doctora Claudia, no hay un solo punto en donde no me abran las puertas, me reciban de mejor manera”, afirmó.
En su intervención, Judith Díaz Delgado, candidata al Senado de la República reconoció la trayectoria de la candidata presidencial y se pronunció contenta de estar “con la mujer que va a continuar con la Cuarta Transformación, con la primera mujer que va a gobernar este país de más de 125 millones de habitantes, con la mujer que viene por-
que puede, porque ya gobernó la ciudad más grande de este país y lo hizo con honestidad, con entereza, con valentía, como toda una mujer de la Cuarta Transformación”. Al encuentro también estuvieron presentes, Waldo Fernández González, candidato al Senado de la República; Néstor Núñez López, coordinador de la Segunda Circunscripción; María Guadalupe Rodríguez Martínez, comisionada nacional del Partido del Trabajo; Anabel del Roble Alcocer, presidenta del Comité Ejecutivo Estatal de Morena y Edgar Salvatierra Bachur, dirigente estatal del Partido Verde Ecologista.
Agendados los debates para candidatos a la Gubernatura

Se espera que participen Norma Rocío Nahle García de la coalición Sigamos Haciendo Historia, José Francisco Yunes Zorrila de la coalición Fuerza y Corazón por Veracruz, así como Hipólito Deschams candidato de Movimiento Ciudadano.
Director General
Lic. Francisco Sánchez Macías
Directora Editorial
Lic. Julia Méndez Campos
El segundo debate será en el Centro de Convenciones del World Trade Center de Boca del Río a las 18:00 horas, el día 12 de mayo de 2024.
El OPLE trabaja en la logística para la organización de los 30 debates de candidatos a la diputación local que se realizarán en el mismo número de distritos electorales. En la sesión se dijo que se buscará que los tres aspirantes a la gubernatura asistan de manera obligatoria a los debates, aunque no impondrán sanciones por no hacerlo.
Finalmente, López Pérez, destacó que los debates contribuyen a la transparencia y rendición de cuentas, aunque no habrá una sanción por no asistir.
El
Jueves 21 de Marz0 de 2024 Primera Sección 2. ESTADO
Heraldo
Tuxpan
una publicación
Editor
tificado
contenido
impreso
por Editora Sánchez S.A.
C.V.,
domicilio en 15 de Septiembre No. 7 Col. La Rivera, Tuxpan, Veracruz. C.P. 92800 TEL. 01 (783) 834 16 73 y 01 (783) 835 58 34. ediciontuxpan@hotmail.com CONTACTO REDACCIÓN diariotuxpublicidad@hotmail.com CONTACTO PUBLICIDAD G R U P O E D I T O R I A L DE VERACRUZ | elheraldodetuxpan.com.mx | Gerente Administrativo Lic. Flor Parrilla Silva
de
es
de lunes a sábado.
responsable Ing. Eduardo Sánchez Macías. Número de Certificado de Reserva de Derecho al Uso Exclusivo del título 04-2016062417532400-101. Certificado de Licitud de Título: 16764. Cer-
de licitud de
16764. Domicilio de la publicación,
y distribuido
de
con
Jefe de Redacción Lic. Misael Leyva Julio Jefe de Información Lic. Teresa de Jesús Blasco Ramírez Jefe de Diseño y Producción LCC Rafael Melgarejo Escudero
Ya se encuentran publicadas las convocatorias
»REDACCIÓN
Tuxpan.- De manera oficial, esta tarde fueron presentados los integrantes del Comité del Carnaval
Tuxpan 2024: “La Alegría de Nuestra Gente”, que se celebrará del 2 al 6 de mayo de este año.
La presentación estuvo a cargo del alcalde José Manuel Pozos Castro; la Lic. Pamela Morales Huesca, presidenta del DIF Tuxpan; la síndica Mtra. Beatriz Piña Vergara; las regidoras y los regidores María del Pilar Martínez Matesanz, Maryanela Monroy Flores, Juan Gómez García, Lucero Reséndis Ambrocio, Luis Demetrio López Marín, y Axel Bernal Herrera; y el Lic. Francisco Villanueva Méndez, director de Turismo
En su intervención, el alcalde José Manuel Pozos Castro destacó que el comité está integrado por personas comprometidas y entusiastas, algunas de las cuales son conocidas por la población tuxpeña debido a que durante muchos años han participado en estas fiestas carnestolendas.
Bajo ese tenor, les agradeció por participar en la edición 127 de festividad que -dijo- es orgullo y patrimonio cultural de Tuxpan.
“Sabemos que es el evento más esperado del año, y esto implica superar los logros alcanzados en la pasada edición, que como recordarán, fue un éxito rotundo. Con la participación de todos, haremos del Carnaval 2024 una celebración a la
Presentan Comité de Carnaval 2024

vida, a la alegría, a la creatividad y a la diversidad”, expresó.
El mandatario invitó a la comunidad artística, a las comparsas, y a organizaciones públicas y privadas, a ser parte de estas fiestas.
Pozos Castro informó que la cartelera artística se dará a conocer en los próximos días, y que estará a la altura de lo que la ciudadanía espera.
“Estamos listos para seguir demostrando a Veracruz, a México y al Mundo, que el amor y la alegría de
Responden feligreses
a actividades religiosas
Aprovechan estos tiempos para fortalecer su fe
LIZBETH ARGÜELLES
TUXPAN
Muy buena respuesta obtiene la Iglesia Católica de parte de sus seguidores, para las diversas actividades que llevan a cabo para celebrar un año más la semana santa.
Los feligreses aprovechan estos tiempos para fortalecer su fe, buscando un encuentro más personal con Dios a través de la oración, la liturgia y la reflexión.
El Párroco de Catedral Matías Reyes, indicó que la Cuaresma es un tiempo
Tuxpan, son inigualables”, concluyó.
El Comité del Carnaval Tuxpan 2024 quedó integrado por el Ing. Raúl Patiño Blanco, presidente; Lic. Alma Delia Hernández Lozano, tesorera; Lic. Gustavo Garamendi Álvarez, logística; Lic. Mónica Ramírez Sánchez, relaciones públicas.
El Lic. Fernando Romano Rivera será el encargado de la difusión y redes; como vocales la Lic. Martha Pérez Silva y el Lic. Juan Zúñiga Martínez; y como asesores hono-
de preparación para la Pascua, la fiesta más importante del cristianismo, por ello invitó a los ciudadanos a seguir los pilares de la oración, ayuno y limosna, que son las prácticas que ayudan a los creyentes a crecer espiritualmente.
La iglesia está ofreciendo un espacio de encuentro y apoyo para vivir la fe en comunidad, pero observan una mayor participación en las celebraciones litúrgicas, en la recepción del sacramento de la reconciliación, en las practicas del ayuno, puesto que la Cuaresma es un tiempo de gracia y renovación para los feligreses, el acudir a la iglesia es una forma de vivir este tiempo con mayor intensidad y recibir los frutos espirituales que ofrece.
Además, indicó que observan muy buena respuesta en los retiros espirituales, en los días de confesiones y en las celebraciones, aunque también esperan participación en los días santos.

rarios Rosita Laso de la Vega y Raúl Serrallonga Basáñez. Durante el evento se dieron a conocer las convocatorias para elegir Reina del Carnaval, Rey de la Alegría, Reina y Rey Infantil, Rey y Reina LGBTQ+, para las cuales el registro de candidatas y candidatos inicia este 21 de marzo y termina el 3 de abril.
De la misma manera, se anunciaron los requisitos y bases para participar en los certámenes de comparsas y disfraces, a los que se

pueden inscribir a partir de la publicación de la convocatoria y hasta el 19 de abril.
El registro se realizará en las oficinas de la Dirección de Turismo, ubicadas en la planta baja de la biblioteca municipal, en el Parque Reforma, de lunes a viernes, de 9:00 a 16:00 horas.
La presentación estuvo amenizada por la batucada de la escuela secundaria Gral. N° 2, “José Vasconcelos”.

Despiden a Elena Larrea, “el ángel de los caballos”
»JUAN DAVID CASTILLA
Xalapa.- La animalista Elena Larrea, considerada “el ángel de los caballos”, fue despedida por sus amigos de la región capital de Veracruz, con un homenaje en Plaza Sebastián Lerdo de Tejada, frente a Palacio de Gobierno, la noche de este miércoles 20 de marzo.
Las personas se concentraron en la escalinata de la Catedral de la ciudad de Xalapa, donde colocaron fotografías, pinturas y veladoras para recordar el gran trabajo de la activista en defensa de los caballos, quien falleció el martes 19 de marzo.
“Las mujeres que se comportan rara vez hacen historia. Elena Larrea cabalga alto, cabalga libre”, se leía en una pancarta que colocaron sobre los escalones.
El animalista Rafael Bravo, amigo de
Elena Larrea, indicó que continuará activo “Cuacolandia”, el santuario para equinos rescatados de maltrato y abandono, con el objetivo de preservar el legado de ella.
Comentó que es colaborador de Cuacolandia, ayudaba en las redes sociales, y era amigo de la activista que murió a causa de una trombosis pulmonar que le ocasionó un coágulo en el pulmón, de acuerdo con un comunicado de Cuacolandia.
Rafael es también presidente de la asociación civil Regalemos un Paraizoo y recordó que Elena era una mujer valiente y luchadora incansable en la defensa de los derechos de los animales.
Él expresó su dolor por la pérdida y su compromiso de continuar cuidando su legado. Por ello, prometió que Cuacolandia seguirá adelante en honor a Elena Larrea.
Elena era influencer y estrella del OnlyFans, cuyos ingresos económicos utilizaba para costear los gastos de Cuacolandia, santuario que se encuentra en Atlixco, estado de Puebla.
Primera Sección Jueves 21 de Marz0 de 2024 .3 LOCAL | elheraldodetuxpan.com.mx |



Exitoso desfile de Primavera
Más de tres mil participantes hicieron de este recorrido una fiesta llena de colores y mucha alegría
Redacción
Tuxpan.- Con motivo del inicio de la primavera, un total de tres mil participantes, pertenecientes a 30 instituciones educativas de nivel preescolar llevaron a cabo un desfile de primavera, a lo largo de la calle Benito Juárez, partiendo de la calle Revolución y concluyendo en la calle Morelos en el primer cuadro de la ciudad, reportándose un saldo
blanco a lo largo de dicha jornada, informó Jorge Arturo García, Director de Educación Municipal.
En un ambiente que se vistió de colores, cada pequeño destiló entusiasmo y alegría representando el inicio de la Primavera en este puerto tuxpeño.
Además de los alumnos de preescolar, se contó también con la participación de las bandas de música
del CETMAR número 20 y las secundarias generales Emiliano Zapata y Manuel Vasconcelos de Santiago de la Peña, mismas que ambientaron el espléndido recorrido en el que se pudo deslumbrar la creatividad de la niñez.
Los participantes del desfile, ataviados con disfraces alusivos a la primavera, bailaron y cantaron al ritmo de las bandas de música, con-

Cumbre Tajín dará poca derrama a
Tuxpan
Visitantes llegan más a Poza Rica y Papantla
»LIZBETH ARGÜELLES
Tuxpan.- Prestadores de servicios turísticos, especialmente los hoteleros y restaurantes, indicaron que las actividades que se generan en la Cumbre Tajín, poca derrama económica traerán al municipio, puesto que se concentra en los municipios de Papantla, Coatzintla y Poza Rica mayormente por la cercanía.
Explicaron que solamente aquellas personas que aprovechan el fin de semana para disfrutar de las playas y de la gastronomía del municipio, podrán buscar a Tuxpan, para disfrutar con su familia.
Mencionaron que quizás un 10 por ciento, pudiera ser derrama económica originada por la Cumbre Tajín, ya que es un evento que
se efectúa precisamente en la zona norte de la entidad veracruzana, aunque en ese punto está más cercano el municipio de Cazones o Papantla, que también ofrecen playas.
Indicaron que tienen ocupación hotelera reservada del 75 por ciento, para el periodo vacacional de la semana santa y esperan que la próxima semana ya tengan un 100 por ciento, y que las condiciones climáticas no cambien como el año pasado para que todos los turistas que hayan reservado puedan llegar sin ningún problema al municipio, ya que anteriormente se ha presentado el fenómeno de frentes fríos en plena cuaresma y lamentablemente esto provoca la cancelación de las reservas.
Empresarios hoteleros mencionan que es importante seguir realizando varios eventos en el municipio, para una mayor derrama económica los trescientos sesenta y cinco días del año y no solamente por temporadas.
Señalaron que, al haber visitantes en Tuxpan, todos los sectores productivos del municipio tienen ganancias, no solamente los hoteleros o los restauranteros, sino también los de las tiendas de la esquina, los supermercados, los mercados, entre otros.
Mencionaron que la difusión del municipio a nivel Nacional e Internacional es necesario y nunca está demás, por ello celebran que las autoridades locales inviertan en la promoción de Tuxpan como el destino turístico ideal.
tagiando de alegría a los presentes, por lo que autoridades educativas agradecieron el entusiasmo y el esfuerzo de cada uno de los participantes para fomentar este tipo de convivencia
A decir de Arturo García, este año se observó una mayor participación de las escuelas, incluyendo estudiantes, docentes y padres de familia, así también se contó con miles
Miguel Ángel Yunes se reúne con simpatizantes
Candidato al senado dialogó con tuxpeños y gente de Tamiahua
»LIZBETH ARGÜELLES
Tuxpan.- El candidato a Senador por la coalición de los partidos PAN, PRD y PRI; Miguel Ángel Yunes Márquez, estuvo de gira por Tuxpan y varios municipios del norte de la entidad veracruzana, sumando adeptos para la próxima contienda electoral.
Señaló que, de llegar al Senado de la República, pugnará porque se regresen los programas de apoyo al Campo, al Sector Pesquero, a la Salud con el Seguro Popular, las financieras rurales para los campesinos, ganaderos, entre otros apoyos que fueron retirados y que hoy necesarios para el sector productivo de la entidad.
de espectadores que se dieron cita a lo largo de la avenida Benito Juárez para presentar los espectáculos ofrecidos por los menores de preescolar.
Dicha actividad marcó el inicio oficial de esta estación en Tuxpan, y se espera que en los próximos días se lleven a cabo otras actividades para celebrar esta época del año.
“Estoy muy preocupado por lo que estoy viendo en todo el estado; de norte a sur hay una gran molestia por la falta de medicinas, y por todo lo que ha venido pasando a partir de que desapareció el Seguro Popular”, expresó. Informó que casi 5 millones de veracruzanos dejaron de tener un servicio de salud de calidad, y ahora la gente no puede acceder fácilmente a una cita con un especialista, además de que no hay medicinas en los hospitales, y no hay la posibilidad de tener de manera rápida una operación.
En Tuxpan, recordó que cuando su papá fue Gobernador del Estado de Veracruz, las obras principales que efectuó fueron el Libramiento Adolfo López Mateos, con concreto hidráulico, destinó muchos recursos para la carretera Tuxpan-Cazones, así como para la ruta de San José el Grande y el puente Ojite, entre otras obras de gran importancia para la población y que hoy en día siguen cubriendo las necesidades de los ciudadanos. Hizo un llamado a los simpatizantes de los tres partidos que conforman la alianza a que trabajen unidos, olvidando viejas rencillas, para que se puedan lograr los objetivos que son que Xóchitl sea Presidenta de México, Pepe Yunes gobernador de Veracruz, Arely Bautista Diputada Federal y él con Sara Ladrón de Guevara, se conviertan en Senadores de la República.

LOCAL Jueves 21 de Marz0 de 2024 4. | elheraldodetuxpan.com.mx | Primera Sección
Llaman a cuidar el agua
El problema de falta del líquido se vive en varios estados
LISETTE D.
TUXPAN
Debido a los graves problemas por el abastecimiento de agua en Tuxpan, en el estado y en general en todo el país, integrantes de diversas Asociaciones Civiles están haciendo el llamado a todas las personas para cuidar el vital líquido.
A través de las redes sociales han emprendido campañas informativas y de concientización para todos los ciudadanos, con la finalidad de que se cuide

y racione el uso del agua, ya que el problema de la falta de este recurso es cada día más preo -
cupante. Comentan que es verdad que en el municipio la depen-

Siguen bajas ventas en mariscos
Sus precios se elevaron con la llegada de la Cuaresma
REDACCIÓN
TUXPAN
Diversas marisquerías y pescadores reportan que continúan las bajas ventas en los productos del mar como pescados, camarones, pulpo, ostiones, entre otros.
Explican que esto se debe a diversos
factores, pero el más importante son los altos precios que manejan en esta temporada, ya que, al ser Cuaresma, época en que muchos creyentes disminuyen el consumo de carnes rojas, hay negocios que aprovechan a subir precios de mariscos.
En este contexto, Enrique H., de oficio pescador, señaló “Entendemos que la economía es complicada, pero si no manejamos precios correctos no tendríamos ninguna ganancia”.
Asimismo, varios ciudadanos explican que han decidido postergar el consumo de los mariscos hasta las últimas fechas de la cuaresma para poder comprar lo suficiente para el último fin de semana que es desde el jueves y viernes santo, ya que tal vez en esas fechas, el precio sea un poco más bajo.
dencia encargada de garantizar el suministro a los usuarios no lo está haciendo, sin embargo,
Nulo trabajo de Genaro afectará al siguiente candidato Tuxpeños ya ni lo recuerdan, y aseguran que se desapareció del distrito
»REDACCIÓN
Tuxpan.- El oscuro y nulo trabajo del actual diputado local por el distrito de Tuxpan, Genaro Ibáñez, pondría difícil el camino de quien resulte abanderado por el Movimiento de Regeneración Nacional para dicho cargo.
En un sondeo realizado a algunos ciudadanos tuxpeños, respecto a si el diputado local había cumplido con los compromisos de campaña, respondieron lo siguiente: “No lo conocí ni en su campaña, y como diputado nunca supe el trabajo realizado en beneficio de los ciudadanos de este puerto y del distrito en general”, señaló Luis Cruz, de oficio carpintero.
Por su parte Sandra Estrada, de profesión
resaltan que dicha situación se vive en todo el país, por lo que es urgente ser parte de la solución como sociedad, y hacer desde nuestras trincheras lo que nos corresponda.
Agregaron que, si en casa gastan en el servicio de pipas, porque la CAEV no da el suministro, se debe inculcar a niños y adolescentes, que, aunque sea algo que sale de los bolsillos de los padres, se debe cuidar el agua.
En ese sentido hacen el llamado a gastar agua en juegos, hacer uso solo de cantidades necesarias, tener la cultura de reciclar u aprovechar el líquido, ser cuidadosos y vigilar qué las llaves no se queden abiertas, entre muchas otras recomendaciones para evitar malgastar el agua.
ingeniero industrial, dijo “La verdad no estoy tan empapada en lo político, pero hay diputados que al menos escucho sus nombres en eventos, pero al que me mencionas, ni idea, tal vez lo escuché en campañas, pero actualmente no sé nada de ese nombre”.
Raquel Juárez, ama de casa, comentó “Sí supe de él cuando fue candidato, pero ya como diputado en mi comunidad no lo volvimos a ver, ya no se supo que hizo, y qué lástima, porque fue de los que solo se acuerdan de la gente cuando quieren su voto, y después se olvidó, como muchos otros”. De las personas interrogadas, no hubo una que recordara el nombre del actual diputado, situación que deja en claro el difícil panorama para que el próximo abanderado que llegue a buscar el voto ciudadano para la próxima contienda.
Cabe recordar que Genaro Ibáñez, en recientes fechas ha hecho acto de presencia entre la población del distrito, toda vez que se inscribió para tener la posibilidad d3 contender nuevamente y repetir en el cargo, sin importarle que los demás años se haya desaparecido por completo, y aunque todavía no dan a conocer el nombre del candidato a la diputación local de este distrito por Morena, se sabe de forma extra oficial que no será Genaro quien cuente con la suerte o fortuna de volver a contender.

| elheraldodetuxpan.com.mx | Jueves 21 de Marz0 de 2024 .5 LOCAL Primera Sección
Inicia vacunación antirrábica
Piden a población llevar a sus perros y gatos que ya tengan un mes de edad o más
AGENCIAS
POZA RICA
La Jurisdicción Sanitaria número 3 se ha sumado a la Jornada Nacional de Vacunación Antirrábica Canina y Felina, la cual estará vigente desde este domingo 17 hasta el 30 de marzo en los Centros de Salud como el de la colonia Anáhuac, en un horario de 09:00 a 15:00 horas.
Durante esta jornada, se aplicará la vacuna antirrábica a perros y gatos a partir del mes de edad. La vacuna debe ser reforzada a los tres meses y nuevamente al cumplir el primer año. Para las mascotas que tienen más de un año, se recomienda aplicar un refuerzo anual.
La Jurisdicción Sanitaria hizo

un llamado a la población para que lleve a sus mascotas a recibir la vacuna, con el objetivo de prevenir casos de rabia tanto en perros como en humanos. Hasta el momento, no se han registrado casos de rabia en esta ciudad.
Una vez que la vacuna sea aplicada, los dueños de las mascotas recibirán un comprobante que deberán conservar. Este comprobante es importante para llevar un registro de la vacunación y asegurar que las

Sitio recreativo, un muladar de basura
Paseo turístico está lleno de desechos y hasta heces humanas
AGENCIAS
POZA RICA
El sitio de recreación conocido como “Raíces de Vida”, ubicado en pleno centro de la ciudad, se ha convertido en un verdadero muladar de basura, cada una de las plazas que conforman este paseo turístico se encuentra repleta de desechos, incluyendo basura, heces humanas y desechos orgánicos.
El regalo que el Sindicato de Trabajadores Petroleros de la República Mexicana (STPRM) hizo a los pozarri-
censes, ha sido utilizado como refugio por personas en situación de calle, generando un ambiente insalubre y un olor nauseabundo. Estas condiciones han generado malestar entre la población, ya que afectan la imagen urbana de la ciudad.
La situación en “Raíces de Vida” es alarmante, ya que lo que solía ser un espacio de recreación y esparcimiento para los ciudadanos y turistas, ahora se ha convertido en un lugar inhóspito y desagradable. La acumulación de basura y la presencia de desechos humanos han generado un alto riesgo para la salud de quienes se aventuran a transitar por estas plazas.
El malestar entre la población es evidente. Los ciudadanos se sienten indignados y preocupados por la falta de acción de las autoridades locales comisionadas en Limpia Pública m, para solucionar este problema. Ante esta situación, es urgente que las autoridades tomen medidas inmediatas para limpiar y rehabilitar este espacio.

mascotas estén protegidas contra la rabia.
La vacunación antirrábica es fundamental para garantizar la salud y bienestar de las mascotas y prevenir la propagación de la enfermedad. La Jurisdicción
Trabajando unidos se hará frente al cambio climático
AGENCIAS PAPANTLA
Al coincidir que el cambio climático solo puede frenarse si los pueblos trabajan unidos y con fundamento en la espiritualidad, conciencia, amor y unión con la madre tierra, esto se informó en el conversatorio denominado Encuentro Internacional de los Pueblos Indígenas sobre el Patrimonio Biocultural, cuyo tema central es el maíz.
En el auditorio Juan Simbrón, del
Sanitaria número 3 invita a la población a participar activamente en esta jornada, llevando a sus mascotas a los centros de Salud designados y contribuyendo así a mantener a la ciudad libre de rabia.
parque temático Takilhsukut y dentro de las actividades de la Cumbre Tajín, representantes de las etnias manawan y mohawk de Canadá, kakawira de El Salvador, así como náhualt de Zongolica y los anfitriones totonacos de Veracruz, se abordó este tema desde el punto de vista de los pueblos originarios.
El tata Gerardo Cruz Espinoza, presidente del Consejo Totonaco de Organizaciones y Comunidades dio la bienvenida a los hermanos Joselyne Laroche, Lise Coocoo Dube y Erik Friend de Quebec, Canadá. Así como a Juan Carlos Rojas de El Salvador y Francisco Cuaquetzale Itehua de Zongolica.
Los ponentes coincidieron en que, aunque la ciencia hace su trabajo por revertir esta situación climática, son los pueblos quienes deben unirse para dejar de contaminar y volver a sus orígenes de armonía y unidad con la naturaleza.

Jueves 21 de Marz0 de 2024 | elheraldodetuxpan.com.mx | 6. POZA RICA Primera Sección

ANUNCIAN FESTIVAL DE LA NIEVE, EN COATEPEC
»AGENCIAS
Xalapa.- Con la participación de más de 30 neveros se llevará cabo la Segunda Edición del Festival de la Nieve en Coatepec, los días 6 y 7 de abril próximos, informó el regidor del Ayuntamiento Coatepec año, Edson Tejeda Corona.
El funcionario municipal señaló que se espera la llegada de más de 20 mil personas que se acerquen a disfrutar de las nieves que se realizan en el Pueblo Mágico.
Este año, adelantó, se realizará un reconocimiento a la mejor nieve
de café.
En la primera edición participaron 25 productores de nieve y este año se espera la llegada de 30 provenientes de Xico, Coatepec, Xalapa, Perote.
“Vendieron el 100 por ciento de sus productos y pues, la verdad, trajeron más de 20 litros. Uno de los requisitos que se les pidió a los participantes fue que nos entregaran los resultados de lo que vendieron”.
Y agregó, “tenemos lo que cada uno vendió, porque digo, sí se vendió el 100% de cada uno, pero ya cuando sumamos todo, fueron más de 8 mil vasitos los que ellos vendieron. Más de 10 mil visitantes”.
Finalmente, destacó que se esperan sabores exóticos en la nieve, como de papa con tequila que traerán los productores de Perote.
Veracruz merece subir de nivel: Nahle
Veracruz, entre las prioridades de la próxima presidenta de México, quien comprometió importante inversión en infraestructura
»AGENCIAS
Boca del Río.- Claudia Sheinbaum será la próxima presidenta de México y Veracruz se encuentra entre sus prioridades, aseguró la Ingeniera Rocío Nahle García.
Destacó que en la última gira por Minatitlán y Coatzacoalcos, Sheinbaum Pardo dio grandes noticias para la entidad a la par que anunció obras que darán aún más certeza de inversión y generación de empleos.
“Anunció ya que vamos a hacer el libramiento de Córdoba - Orizaba, ya se comprometió, el distribuidor para el acceso al puerto de Veracruz, con una larga visión, una visión a 20, 30 años, las carreteras en el norte de Tantoyuca- Tuxpan la verdad es importantísima”, resumió Rocío Nahle.
Agregó que otro compromiso de Sheinbaum Pardo fue ampliar y dar mantenimiento a las carreteras 180 y 150.
“Hay que darles un mantenimiento, van hacia el sur, lo más importante, vamos a reactivar

la petroquímica nacional en Coatzacoalcos y Minatitlán”, apuntó. Nahle García agregó que mientras la oposición busca denostar, la Cuarta Transformación avanza porque los veracruzanos están informados.
“En Morena, nos concentramos este fin de semana en recibir a la próxima presidenta de México que anunció importantes proyectos en Veracruz, eso es lo más importante de todo, donde vamos a trabajar de la mano con ella, por ejemplo”, concluyó.

Jueves 21 de Marz0 de 2024 .7 ESTADO | elheraldodetuxpan.com.mx | Primera Sección



Floración adorna cafetales
Se registra primera etapa en cultivos
»AGENCIAS
Coatepec.- En la región de Coatepec comenzó la primera etapa de la floración en los cultivos de café, por lo que se augura una buena cosecha para el ciclo 2024-2025. Una flor blanca con forma de estrella adorna los cafetales en el ejido La Orduña,
cuyo acceso es por el libramiento del Pueblo Mágico, en la región capital de Veracruz.
De acuerdo con Cirilo Elotlán Díaz, integrante del Consejo Regional del Café de Coatepec, las recientes lluvias favorecieron a las floraciones de café, lo que es una buena noticia para los productores. “Estamos ya en la primera etapa de las floraciones de café en campo. Eso es muy interesante porque se augura una buena cosecha para el 2024-2025, porque además llovió y eso favorece mucho a las floraciones de café. Ese es como la noticia
buena”, expresó. La primera etapa de floración inició esta semana. Los cafetaleros estiman que la segunda etapa sea en abril y la tercera en mayo. La cosecha se espera que sea normalizada en noviembre, diciembre, enero y febrero.
Elotlán Díaz explicó que la producción de café ha bajado en sus fincas, debido a la degradación del suelo, el envejecimiento de las plantas y la falta de inversión en tecnología.
El entrevistado comentó que también se trata de un mensaje claro de la naturaleza sobre el deterioro de la

Refuerzan acciones contra el Dengue
Implementan jornadas en las 11 jurisdicciones sanitarias de la entidad
AGENCIAS
XALAPA
Desde el pasado lunes y hasta el 22 de marzo se llevará a cabo la Primera Jornada Nacional de Lucha contra el Dengue 2024 en las 11 jurisdicciones sanitarias del estado de Veracruz, informaron las autoridades de la Secretaría de Salud, a cargo de Guadalupe Díaz del Castillo Flores.
A través de un comunicado, SESVER destacó que se continúan con las actividades de control del mosquito trans-
misor del Dengue, Aedes Aegypti en Veracruz.
Se dió el banderazo de esta jornada en los municipios de Pánuco, Tuxpan, Poza Rica, Martínez de la Torre, Teocelo, Córdoba, Río Blanco, Veracruz, Cosamaloapan, San Andrés Tuxtla y Coatzacoalcos.
Las autoridades sanitarias indicaron que se fortalecerán acciones de control y prevención de enfermedades transmitidas por vector como son Dengue, Zika y Chikungunya.
“A través de las 11 Jurisdicciones Sanitarias del Estado, se coordinaron eliminaciones masivas de criaderos, junto con ayuntamientos y escuelas, disminuyendo la posibilidad de que se reproduzca el mosquito transmisor de Dengue”, dice el documento.
Asimismo, llamaron a las y los veracruzanos a sumarse a esta estrategia de eliminación de criaderos de larvas del mosquito transmisor a través de la campaña permanente de Lava, tapa, voltea y tira.
biodiversidad y la supervivencia de la humanidad.
“Ahorita es la primera floración que se está dando en campo, está propiciando un clima idóneo para una excelente floración ahorita. La segunda viene en abril, es la segunda, que es la central, creo que va a ser mucho más abundante que la de ahora, y la tercera va a ser en mayo, que es ya para el cierre de las floraciones y ya después viene el desarrollo del producto, del fruto”, reiteró.
El productor detalló que la cosecha pasada se adelantó a septiembre-oc-
Se reportan 17 casos de trata de personas
En Veracruz, los casos de trata aumentaron 83.3 por ciento de 2022 a 2023
AGENCIAS XALAPA
Durante los últimos años repuntaron los casos de trata de personas en el estado de Veracruz, cuyos valores porcentuales son de los más elevados a nivel nacional.
De acuerdo con el Observatorio Ciudadano del Instituto de Gestión,
tubre y concluyó en noviembre. Los cafetaleros resultaron afectados porque tuvieron que invertir antes de tiempo en el proceso para el corte del café cereza y muchos no lograron hacerlo, perdiendo parte de su producción.
Hace 15 o 20 años una mata de café producía 20 kilogramos de cereza, pero en la actualidad solo produce entre cuatro y cinco kilogramos.
Los cafetaleros de Coatepec cultivan un producto de calidad, que son los arábicas, catimores y otros tipos que dan una excelente calidad en taza.
Administración y Vinculación Municipal (IGAVIM), en Veracruz los casos de trata aumentaron 83.3 por ciento de 2022 a 2023.
Durante los años mencionados se contabilizaron 17 casos de trata de personas en distintos municipios veracruzanos.
Algunas autoridades estatales continúan sin reconocer que hay incidencia de este delito en la entidad.
A nivel nacional, disminuyó el delito de trata de personas 9.35 por ciento al comparar 2023 con 2022, presentando indicadores negativos en 11 entidades federativas.
Quintana Roo es la entidad donde más aumentaron estos casos, pasando de 37 en 2022 a 87 en 2023.
Lo anterior representa un porcentaje del 135.1 por ciento. Mientras que en Puebla se habla de un aumento del 86.8 por ciento.

| elheraldodetuxpan.com.mx | ESTADO Jueves 21 de Marz0 de 2024 8. Primera Sección
Hay una bolsa de 10
MDP para los ganadores
AGENCIAS
XALAPA
La Secretaría de Medio Ambiente del Estado de Veracruz (SEDEMA) lanzó la convocatoria de la tercera edición de “Proyectos para el Fomento Ambiental 2024”, en la que se tiene una bolsa de 10 millones de pesos para los ganadores.
Al respecto, la directora de Vinculación Social y Cultura Ambiental de la SEDEMA, Brenda Joan Soto, informó que la convocatoria que fue publicada el martes 19 de marzo y estará vigente hasta el 22 de este mes, recibirá proyectos en tres líneas estratégicas: conservación, restauración y prácticas sustentables.
La invitación está dirigida a municipios, instituciones educativas y personas físicas, que tengan proyectos que beneficien e impacten al medio ambiente.
“Tenemos una bolsa de 10 millones de pesos, estamos apo-
Lanzan convocatoria para proyectos ambientales

yando hasta con 500 mil pesos a los proyectos, la edición anterior se beneficiaron 23 proyectos, entre ellos algunos humedales como el de Naolinco, otro en Martínez de la Torre, así como viveros en el Tecnológico de Huatusco y otro más en el municipio de Atoyac que hizo un vivero grande para reforestación”.
La funcionaria de la Secretaría
de Medio Ambiente refirió que en las ediciones anteriores se recibieron más de 200 proyectos, sin embargo, no se puede apoyar a todos, por lo que se hace una evaluación y se pasan al jurado dictaminador.
“La convocatoria se encuentra en la página de SEDEMA, redes sociales tanto del secretario Juan Carlos Bautista Contreras y de

ALUMNA METE AGUARDIENTE Y
PASTILLAS,
EN TÉCNICA 3
»JUAN DAVID CASTILLA
Xalapa.- El operativo mochila será aplicado en la escuela secundaria Técnica Industrial número 3 de la ciudad de Xalapa, luego de un incidente, donde se detectó que una alumna llevaba medicamentos de uso controlado combinados con licor y bebidas energéticas en un recipiente.
La determinación se tomó en consenso con las madres y padres de familia para evitar que los estudiantes estén expuestos a sustancias que son nocivas para su salud.
“En la escuela se presentó un incidente la semana pasada con los recipientes que llevan los niños de casa, una alumna llevaba caña combinada con pastillas de un medicamento controlado (se supone porque tenía restos blancos abajo del recipiente de agua) con caña (aguardiente) y bebidas energéticas”, se
alertan los papás en chats de WhatsApp.
A los tutores se les pidió que firmaran una carta de autorización para la implementación del operativo mochila en el plantel educativo, ubicado sobre la avenida Manuel Ávila Camacho.
Algunos papás dieron a conocer que están de acuerdo con dicha medida preventiva en la escuela secundaria, para garantizar la integridad del estudiantado.
Se requería del consentimiento de los padres para evitar la vulneración de los derechos humanos de los menores, cuya edad va de los 12 a los 15 años, en promedio.
“Esas bebidas ocasionan que se desvanezcan y empiecen a vomitar al poco tiempo de tomarlo, se tomaron medidas médicas para apoyarlas, pero al no tener la aceptación de los papás y culpar a la escuela nos vemos en la medida de pedirles su autorización para el operativo mochila que se realizará en conjunto de los directivos de la escuela y la asociación de padres de familia, con la finalidad de salvaguardar la seguridad de los menores”, indicaron.
Por lo anterior, de manera sorpresiva y periódica, serán revisadas las mochilas de los estudiantes en la escuela Técnica 3.

la dependencia, los invitamos a seguir realizando prácticas para el medio ambiente, sobre todo ahora que nos enfrentamos a retos como el cambio climático”.
Brenda Joan Soto insistió en que la convocatoria se cierra el
Alerta por brote de Guillain
Barré
Ya se reporta un fallecido
»AGENCIAS
Xalapa.- La titular de la Secretaría de Salud de Veracruz, Guadalupe Díaz del Castillo Flores aseguró que se mantienen en alerta ante el brote de casos de Guillain-Barré en el vecino estado de Tlaxcala, enfermedad que ya reporta un fallecido.
En entrevista, aseguró que se trata de un padecimiento que se genera por distintos motivos, aunque generalmente es autoinmune, pero también puede derivar de virus estomacales.
“Aquí nos mantenemos con las incidencias esperadas, es una enfermedad que se presenta, pero aisladamente, no en un grupo o pull de personas, entonces en ese sentido, aun con la cercanía, el caso de Tlaxcala estu-
próximo 22 de marzo a las 12 de la noche, para llevar a cabo la premiación el 8 de abril a quienes resulten ganadores.
La convocatoria la puede consultar en el siguiente enlace: https://acortar.link/qCeDIZ
vo asociado a un brote, aquí también damos atención muy cercana cuando se presenta un brote, establecemos cuál es la fuente de contaminación y la atacamos directamente”.
La también directora de los Servicios de Salud de Veracruz confió en que los casos presentados en Tlaxcala se limiten solo a esa circunscripción, pero aun así las autoridades sanitarias veracruzanas se mantienen en alerta.
Llamó a la población a mantener las medidas preventivas, como es el lavado de manos frecuente, cocción adecuada de alimentos y evitar consumir mariscos crudos.
“La asociación que hubo en Tlaxcala fue por alimentos, todas las medidas preventivas abonan a no tener casos”.
Asimismo, Díaz del Castillo Flores insistió en que la incidencia en Veracruz de esta enfermedad es esporádica, la mayoría de los casos autoinmune “tenemos la presencia, pero es lo esperado”.
Hay que recordar que en el estado de Tlaxcala se reporta a 66 pacientes con síndrome de parálisis flácida aguda, de los cuales 26 dieron positivos a Guillain-Barre y el día de ayer (martes) se notificó de la defunción de un hombre de 48 años, el caso está asociado al consumo de pollo contaminado.

Jueves 21 de Marz0 de 2024 ESTADO .9 | elheraldodetuxpan.com.mx | Primera Sección
En la entrega está la felicidad, no en el vivir, sino en saber donarse sin miedo, haciendo corrección cada día. Al igual que, con el despertar de cada mañana entramos en acción, los acontecimientos tampoco representan una mera sucesión de actos sin sentido; pues, aunque estemos bajo el dominio del caos, tenemos voluntad para reafirmar la personalidad, templar el carácter y desafiar la adversidad, superándonos diariamente.
En efecto, debemos cultivar nuestros quehaceres cotidianos con los atributos de amor y bondad. Sin exclusión alguna, hemos de tomar conciencia de que son las pequeñas cosas que nos ocurren a diario, las que nos refuerzan y dan aliento a proseguir en los sueños, haciendo camino y rehaciendo rutas que nos lleven a un espíritu de concordia.


ALGO MÁS QUE PALABRAS
EN SABER VIVIR PARA LOS DEMÁS, SE UBICA LA DICHA
VÍCTOR CORCOBA HERRERO
De ahí, la importancia de que los gobiernos y las organizaciones internacionales ejemplaricen sus actuaciones, invirtiendo en condiciones que favorezcan la prosperidad, no en una suma de intereses mundanos, sino en la defensa de los derechos humanos para todos, que es lo que verdaderamente incorpora la dimensión del bienestar global.
Ciertamente, la humanidad es más feliz cuando todos estamos unidos, con brío cooperante y grafía solidaria. Sin duda, nos apremia ahuyentar este espíritu guerrero que nos asfixia con el veneno del enfrentamiento permanente y pasar al cultivo del auténtico abrazo.
Desde luego, hay muchos factores que influyen en la duración existencial de cada uno de nosotros, pero tener una perspectiva generosa, seguro que nos recompensa, injertándonos una
BRÚJULA
LA PROPIEDAD DE CLARA
ANA PAULA ORDORICA
Tras el primer debate entre los candidatos a la Jefatura de Gobierno de la CDMX hubo quien vio a Clara Brugada, la candidata de Morena-PT-PVEM, como la ganadora. No por su espectacular desempeño frente a Santiago Taboada, candidato del PAN-PRI-PRD, y de Salomón Chertorivski, de MC. Más bien porque al ser la puntera y no haber recibido un nocaut durante los 90 minutos del encuentro, pues la conclusión de algunos fue que Brugada ganó.
Pero en los debates no solamente se gana durante los minutos que dura el encuentro. En especial con el formato de debates que tenemos en México. No son debates. No vemos a los candidatos teniendo que responder a las preguntas de los moderadores. Por el contrario. En el colmo de los colmos, a lo largo del debate los moderadores les preguntaban a los candidatos si querían responderles sus preguntas. Tampoco tienen que responder a los cuestionamientos que se hacen entre ellos. Son monólogos en los que ofrecen el oro y el moro y no tienen nada que perder.
Ya sabemos que prometer no empobrece, pero en el caso de las campañas políticas en México, prometer es justo el juego de los candidatos. Podrían decir que si ganan van a hacer que lluevan chispas de chocolate sin que tengan que responder ¿cómo le vas a hacer? O ¿cómo lo vas a pagar?
Dado el esquema tan pobre de los debates, es muy difícil realmente que alguno de los candidatos cometa un nocaut. Es justo por ese miedo de los contendientes a que le saquen sus trapitos al sol o a
sensación general de complacencia. En efecto, no es el dinero, ni las cosas materiales, las que nos sustentan en las relaciones sólidas, sino el soplo desprendido que nos acompaña inherente, para que cada aurora todo sea esperanzador. Dejarse llevar por lo que uno anhela es un buen propósito para llegar lejos. Ser buenas personas para ganar confianza consigo mismo, también nos ayuda a no perder el tiempo, porque son los vínculos humanos compartidos y rehechos en confianza, los que nos permiten alcanzar mayor cantidad de proyectos. Al fin y al cabo, no existe gran talento sin perseverancia y buen talante, por mucha titulación que poseamos, lo sustancial es hermanarse. Quizás sea el momento de iniciar nuevos itinerarios conjuntos, tras haber pregonado el absurdo del “tanto tienes/tantos
que cometan un error que se han empeñado a un formato acartonado y aburrido.
Por ello, el post debate se vuelve interesante. Y en el caso del Debate Chilango la que ha tenido que salir a defenderse ha sido precisamente Brugada. En el encuentro del domingo, Taboada le señaló un inmueble que compró en $330 pesos y que encima de todo no lo declaró. Por el formato, después de que Taboada habló de este inmueble de Brugada el tema ya no se volvió a tocar. Los moderadores pasaron al siguiente tema y Brugada feliz de dejarlo ahí.
Pero ha sido en el post debate cuando la candidata de Morena ha salido a admitir que sí hay tal inmueble y que hubo un error ya que consignó primero solamente el costo de la escrituración de la propiedad en lugar del costo del inmueble y por ello aparece como que le costó $330 pesos. La explicación es mala ya que tampoco es creíble que escriturar un inmueble cueste trescientos pesos.
La periodista Laura Bruges publicó un hilo con información adicional sobre esta compra de Clara. La propiedad fue inscrita ante el Registro Público de la Propiedad del entonces DF en octubre de 1993 por la Comisión para la Regularización de la Tenencia de la Tierra (CORETT), hoy Instituto Nacional del Suelo Sustentable, dependiente de la SEDATU. Brugada adquirió este inmueble a precio de ganga a través de una compraventa el 29 de junio de 1994, y la vendedora fue la misma Comisión para la Regularización de la Tenencia de la Tierra. Ante tantas irregularidades, se explica porque Clara no declaró su compra.
vales”, haciéndonos esclavos como jamás, de una soledad sin consuelo.
Además, la experiencia vivencial nos demuestra, que no se es feliz por el simple hecho de satisfacer las expectativas y las exigencias mundanas, sino por el amor que se imparte, renunciando a la mera posesión. Con razón, siempre se ha dicho: renovarse o morir. Sabemos que, por desgracia, la sociedad moderna está hondamente irrumpida por el encantamiento de las fortunas adineradas.
Deberíamos, por tanto, desmoronar este falso filtro de poder y pensar en nuestra capacidad de servir, no de servirnos de nadie. Una vez liberados del apego a los bienes terrenales, estoy convencido de que todo será más llevadero, porque habrá otro ánimo, de no atesorarse de nada y sí de fraternizarse.

OPINIÓN
Reconozco, que jamás he podido concebir, cómo una persona perseguía la alegría ejerciendo la dominación y practicando el egocentrismo. Sin embargo, el querer lo es todo en la vida y, si aspiramos ser felices, con tesón hasta los cantos tendrán su encanto.
A partir de esta convicción mística, se desarrolla una auténtica rebelión mar adentro para no desesperarse ante las hazañas de los poderosos, que todo lo suelen revestir de puro egoísmo, con criterios de maldad y razonamientos corruptos. Hoy más que nunca, es necesario cultivar la dedicación a los que nadie quiere acoger, sin caer en la infamia de la usura que arruina la vida de los desfavorecidos, poniendo de relieve que el cumplimiento de la ley moral es fuente de profunda paz interna.
BUSTER KEATON, EL SEMBLANTE ESTOICO DE LA COMEDIA
Tres grandes comediantes, Charles Chaplin, Harold Lloyd y Buster Keaton, dominaron el arte del gag en el cine mudo, ese acto de comicidad que se escenifica sin palabras. Sus rutinas personificaban la tragedia del hombre común en una época que pasó de la bonanza a la depresión económica de los años veinte del siglo pasado. El apodo de “búster” se lo puso el famoso escapista Harry Houdini, cuando vio que de niño se rodó unas escaleras y se levantó ileso.
Buster Keaton, conocido como “Cara de piedra”, es el gran comediante que hizo reír a millones y él nunca sonrió.
Nacido en 1895 en Kansas, fue único hijo de una pareja de actores en teatros y revistas musicales. En su vida de joven surgió el cine, uno de los cambios tecnológicos más sorprendentes, que pasó de la fotografía fija a la imagen en movimiento. No obstante, el cine estaba restringido por la falta de sonido, por ello la imagen, la expresión facial, las miradas y las escenas de acción dominan hasta la fecha este nuevo espectáculo que se convertiría en la más nueva expresión de las artes.
Roscoe “Fatty” Arbuckle fue el primero que identificó el gran talento de Keaton, quien lo definía como “el pequeño personaje de cara triste”. Después de sus primeras cintas logró comprar los estudios que dejó Chaplin, y ahí Keaton pasó de simple comediante a un creador, productor y director de sus propias películas.
Keaton fue el actor solitario, delgado, de facciones angulosas, su cuerpo parecía frágil, que lograba dominar riesgosas escenas. A su vez era dueño de una excepcional capacidad de transmitir emociones casi sin parpadear o gesticular su cara, que era su más poderoso instrumento de actuación.
Es recomendable la película “Sherlock Jr.” de 1924, que por su genial creatividad se ha retomado en muchas alegorías en el cine moderno, y la obra maestra “El Maquinista de La General”, donde filmó sus más famosas escenas en la máquina de un tren. En el frente de una locomotora o en su costado, la expresión trágica solemne, con asombrosa capacidad de coordinación escénica logró hacer cambios de cámara y de tomas con gran sincronía.
En esos tiempos no se tenía definida la función de los “dobles” para las escenas peligrosas, lo que le daba al actor un mérito adicional.
La genialidad de su creatividad no tenía un guion preconcebido sino una serie de episodios chuscos encadenados en una improvisación creativa, que a veces requería más de 20 tomas hasta que se lograba el efecto deseado.
Un pasaje interesante de su vida fue su papel en el teatro en la famosa obra de teatro Esperando a Godot, de Samuel Beckett, de la que también fue protagonista, en la película “Film”, en donde se había considerado inicialmente Chaplin y se reconsideró la oferta para integrar a Keaton al papel protagónico.
Jueves 21 de Marz0 de 2024 | elheraldodetuxpan.com.mx | 10. OPINIÓN Primera Sección
MIGUEL ALEMÁN
Después de haberse obtenido los datos de inflación en Estados Unidos, en el segundo mes del año, se confirma la expectativa de que el ajuste en tasas podría darse hasta junio e incluso retrasarse si los precios al productor se aceleraran.
El Bureau of Labor Statistics dio a conocer que la inflación pasó de 3.1% a 3.2% a tasa anual en el segundo mes del año, y estuvo 2.8 puntos porcentuales por debajo del dato de febrero de 2023. Empero, la expectativa de los especialistas era de estabilidad en los precios, lo que significa que la posibilidad de un recorte inmediato en los


tipos de interés se disipó.
La inflación, mes a mes, pasó de 0.3% en enero a 0.4% en febrero, en línea con lo esperado, pero registrando su mayor avance en cinco meses. Asimismo, la subyacente, que excluye los precios volátiles de energía y alimentos, se moderó en la estimación mensual (0.4%) y en términos anuales llegó a 3.8% en febrero vs. 3.9% en enero, siendo el crecimiento más bajo desde mayo de 2021.
Sin embargo, una inflación anual mayor a la esperada y lejana a la meta de 2%, y que obedeció a incrementos, principalmente en los pasajes
OPINIÓN
TASAS EN ESTADOS UNIDOS BAJARÁN, PERO CON MODERACIÓN
de avión, precios en vivienda y de gasolina (éstos últimos dos índices contribuyeron con más de 60% del incremento mensual), es un resultado que evidencia que el poder adquisitivo de los estadounidenses aún no se recupera; siendo esto un tema de disputa en el periodo electoral.
El mercado espera que la tasa de referencia, ahora en un rango de 5.25% - 5.50% y que llegó a este nivel tratándose de contener una inflación de casi dos dígitos en junio del 2022, empiece ya a bajar para estimular el consumo y la inversión vía créditos más
accesibles. Empero, la Reserva Federal (Fed), se mantiene cautelosa de no hacer ningún movimiento anticipado y espera señales de una baja más duradera en la inflación para poder accionar un relajamiento monetario.
Lo que es indudable es que, si la trayectoria de precios fuera descendente, como se espera, la Reserva Federal comenzaría a bajar su tipo de interés a mediados de año. El mercado laboral se mantiene fuerte y no muestra signos de debilidad, la economía no cayó ni caerá en recesión, pero con un crecimiento continuo, aun-
que menor que el año pasado y esto abona a la flexibilización monetaria. Solo que, de seis a siete recortes esperados en tasas de interés en el año, ahora solo serían dos o tres. El balance que hace la Fed es un equilibrio delicado entre crecimiento e inflación y debe tener precaución en no caer en un recorte rápido o demasiado, que pueda traer a la postre consecuencias que impliquen un rebote posterior inflacionario. Los inversionistas, tendrán entonces que ir ajustando su perspectiva de la primera baja de tasas de interés.
OPINIÓN OPINIÓN
LOS JÓVENES SÍ CONSUMEN MÚSICA
CLÁSICA: ANA
RAUDEL ÁVILA
La doctora Ana Gabriela Fernández es originaria de Cuba. Tiene una maestría y un doctorado en interpretación musical por la UNAM, donde se tituló con mención honorífica. Ha tomado clases magistrales con André Laplante, Evelyne Brancart, Lilya Zilberstein, André Watts y Dang Thai Son. Sus grabaciones discográficas incluyen Violinesque (2011), Grupo de Renovación Musical. Julián Orbón (2013), Entre bocetos y sonatas (2016). Ha actuado como solista con la Orquesta Sinfónica de Aguascalientes, la Sinfónica de Minería, la Orquesta Filarmónica de la Ciudad de México, la Orquesta Sinfónica Nacional y otras tantas en México, Cuba y otros lugares.
Usted es aficionada a la literatura, no solo a la música. ¿Me puede hablar un poco de los vasos comunicantes entre música y literatura en general?
Desde que soy niña siempre he tenido una fascinación por las obras de los grandes compositores de la música clásica universal que han mirado hacia otras manifestaciones artísticas, en este caso la literatura. Un ejemplo es la sonata en si menor de Franz Liszt basada en el Fausto de Goethe. Si no conoces la obra, no puedes interpretar la música, aunque tengas las capacidades técnicas o tengas resuelto el tema interpretativo.
Una parte importante para lograr una interpretación honesta es conocer de qué va la música que estás tocando. La sonata en si menor es una de las grandes obras que se han escrito para la literatura pianística y siento que es una parte muy importante de Franz Liszt que deja mucho de lado este espectáculo técnico del que era conocido en su época y por lo que la mayoría de las personas (conocedoras y no conocedoras) ubican a Franz Liszt.
Esta cosa del espectáculo técnico, esta figura del pianista como rockstar. De modo que la sonata en si menor es el primer ejemplo que te pudiera dar de la relación muy cercana entre literatura y música. El otro ejemplo que creo
GABRIELA FERNÁNDEZ
que es fundamental es el Gaspard de la nuit de Maurice Ravel. Está basado en tres poemas de Aloysius Bertrand yo recomiendo la interpretación de Martha Argerich, que es una de las pianistas que más sigo y con las que más me conecto. Tengo con ella una conexión profesional y personal.
Si no conoces los tres poemas, aunque toques la música, desde mi perspectiva no puedes llegar a una interpretación idónea o cercana con la obra literaria. Vas tocando la pieza y es como si estuvieras en cada parte del poema. Cada parte de la música responde al poema en su versión original. Cuando interpretamos una pieza estamos contando una historia con sonidos. Parte importante del proceso creativo que es tan complejo, es leer entre líneas en la partitura.
Cuando uno lee un poema o una novela, o un ensayo, hay puntos, comas, comillas, palabras más importantes que otras. Hay un acercamiento de expresividad con el texto como también lo debes tener con el texto musical. Hay partes de la pieza más importantes, hay un clímax, hay notas más significativas. Se debe tener un acercamiento al discurso musical de manera narrativa porque estás contando una historia.
Es fundamental que los pianistas miremos a otras manifestaciones artísticas, por lo general no nos gusta leer mucho. Nos gusta sentarnos al piano y hacer la parte práctica que es esencial, el trabajo duro de las primeras etapas. Es indispensable que los pianistas y músicos leamos poesía, que veamos buen cine de autor.
Mucha música de nuestro repertorio está utilizada por grandes cineastas en películas muy importantes de la historia del cine. También uno tiene que ver de qué manera el cineasta usa esa música. Eso puede ser de ayuda para tener otra concepción de la obra. Te podría poner de ejemplo esas dos piezas, pero hay otras muchas que sostienen esa relación con la literatura.

MÉXICO
GERARDO
Mucho está en juego para la Selección Mexicana en su regreso a la actividad, en este 2024: Ganar la Nations League y ser semifinalista en la Copa América, son sus obligaciones.
No hay forma de eludir estas responsabilidades, su deber es cumplir los objetivos trazados Es sumamente importante hacerse cargo de los compromisos adquiridos, para evitar una nueva crisis, otro caos en el futbol mexicano.
Jaime Lozano, su cuerpo técnico y todo lo que han puesto a su alcance para mantenerlo como entrenador, requieren encontrar la estrategia adecuada para eludir el final del ciclo con la Selección.
Hablemos del torneo de la Concacaf, ya de la Copa América habrá tiempo suficiente.
El ahora famoso Final Four representa el primer gran escenario para México, porque —de entrada— precisa vencer a Panamá, uno de los equipos que más crecimiento ha tenido en el área y el cual le complicó la vida en la final de la Copa Oro del año pasado.
Si avanza, tendrá que medirse —seguramente— a Estados Unidos, que —en teoría— no debe tener demasiados problemas para superar a los jamaicanos.
Sorprende, y hasta coraje da decirlo, pero la Selección Mexicana no es la favorita para ganar este torneo de la Concacaf.
Llega al evento como el peor clasificado de los cuatro contendientes, resultado de la sufrida eliminatoria contra Honduras hace cuatro meses.
Nuestra Selección, lamentablemente, tiene que ver hacia arriba a Estados Unidos, porque es el campeón, porque ha convocado a su plantilla estelar (21 de los 23 llamados juegan en el extranjero) y los estadounidenses son los candidatos más fuertes para triunfar y conseguir el tricampeonato.
Tremendo reto para México, espero tenga el coraje para dominarlo.
Jueves 21 de Marz0 de 2024 .11 OPINIÓN | elheraldodetuxpan.com.mx | Primera Sección
VORITO
GANAR LA NATIONS LEAGUE
NO ES FA-
PARA
LAURA ITURBIDE
MELÍN





JUAN ZUÑIGA.
Qué tal queridos lectores, ya estamos de regreso con más fotos y comentarios de nuestra gente linda.
Hoy como pueden ver nos acompañan grandes amigas que disfrutaron un deliciosa y amena tarde de charlas y buena convivencia, la cual no puede faltar en reuniones o encuentros de grandes amigas.
Que mejor manera de comenzar que enviando un saludo y una enorme felicitación para nuestros amigos de la banda Radio Umbral una banda musical 100% Tuxpeñas, la cual estuvo presente el día martes en la inauguración de Cumbre Tajín 2024, en donde compartieron el escenario con otras grandes bandas, así como artistas de taña internacional. Muchísimas felicidades Radio Umbral y que continúen los éxitos.
Un enorme gusto poder saludar en días pasados a nuestra apreciadas Damas Promotoras de Marina, a ellas las captamos disfrutando de la pasarela con causa, organizada por las damas del Club Rotario Huasteco.
Amigas de toda la vida son sin duda las señoras, Sarita Ortiz, Lucy Rocha, Mago Quero y Julia Farías, todas encantadas de la vida recibieron nuestro lente.
Una reunión de amigas fue la que disfrutaron, Erika Farías, Marianela Monroy y Josefina Rebolledo, enormes saludos para ustedes.
Saludotes para quien engalana nuestra sección de hoy, nos referimos a nuestra guapa amiga Susana Rabanal Bautista, saludos a ella y no olviden seguirla a través de sus redes sociales de MARIA BONITA en donde encontraran grandes sorpresas.
Guapísimas, madres e hijos, nos referimos a Dona Abresch y Natasha Núñez y Laura Castan y Galeana López, saludos y gracias por las poses para la foto del recuerdo.
Nuestro agradecimiento a todas las que atentas posaron para la camarita, desde estas líneas les enviamos cordiales saludos. Mañana regresamos con más. Que tengan un día maravilloso.
| elheraldodetuxpan.com.mx | Primera Sección Jueves 21 de Marzo de 2024 12. ESTILOS
Excelente grupo de Damas Promotoras de Marina.
Damas Promotoras de Marina.
Laura Castan y Galeana López.
Karen Navil.









| elheraldodetuxpan.com.mx | Primera Sección Jueves 21 de Marzo de 2024 .13 ESTILOS
Dona Abresch y Natasha Núñez.
América Acosta, Alba Zabala y Roció Martínez
Susana Rabanal Bautista
Radio Umbral, banda 100% Tuxpeña, presentes en la apertura de Cumbre Tajín 2024.
Erika Farías, Marianela Monroy y Josefina Rebolledo
Noé Rivera, Victoria González y Anita Rincón
José Eduardo y Zaira Valeria
Sarita Ortiz, Lucy Rocha, Mago Quero y Julia Farías

Lozano se sincera sobre el Tata en Selección Mexicana
AGENCIAS ESTO
Jaime Lozano habló sobre la etapa de Gerardo Tata Martino con la Selección Mexicana, y aunque reconoció la trayectoria que tiene como entrenador, dijo que él siguió de cerca sui trabajo y no hubo un momento donde lo tratara mal: “Nunca me van a escuchar hablar mal de Gerardo”.
En conferencia de prensa, el Jimmy dijo que todos pueden opinar lo que quieran, ya que tanto Edson Álvarez como y Andrés Guardado finalmente se han decidido a hablar sobre qué pasaba en el ambiente de la Selección rumbo al Mundial de Qatar 2022. En ese sentido, Lozano aclaró que sólo podrá elogiar al Tata por haberse entregado al máximo a su manera.
“Algo me enteré de que se abrió la
París
caja de pandora como dices y cada quien es libre de comunicar lo que quiera, cada uno tiene una verdad y la forma de ver su situación; yo no tengo más que buenas palabras para Gerardo Martino, a mí y a mi cuerpo técnico nos trató de maravilla “, dijo.
Tanto a Jaime Lozano como a los aficionados mexicanos les decepcionó la pronta eliminación en fase de Grupos de Qatar 2022. México no quedaba eliminado en esa etapa desde Argentina 1978, y definitivamente el ahora técnico del Tri mayor recalcó que eso se debió a que llegaron en un mal momento futbolístico y anímico.
¿Por qué México fracasó en Qatar 2022? Jaime Lozano opina al respecto
“Estuve muy pegado a él y vi que trabajó, después los resultados estoy seguro de que él y todos nosotros hubiéramos querido que fueran dis-
2024: Fechas y horarios de los torneos
AGENCIAS
ESTO
Las fechas y horarios de los torneos varonil y femenil de futbol para París 2024 ya se definieron. El Comité Olímpico Internacional presentó el cronograma de los encuentros del certamen, además de que se realizó el sorteo para la fase de grupos de las competencias del balompié.
El futbol comenzará el 24 de julio, dos días antes de la inauguración de París 2024, aunque será el futbol varonil el que entrará primero en acción. La femenil comenzará las hostilidades el 25 de julio.
tintos, pero es futbol y creo que la emoción y momentos importan muchísimo en esto y creo que no fue el mejor momento en el que se llegó a la Copa del Mundo”, aclaró.
Finalmente, el Jimmy espera poder tener el respaldo de los jugadores para su proceso, sobre todo ahora que empiezan los juegos importantes, tales como el Final Four ante Panamá y la Copa América en este verano, ya que no habrá eliminatoria porque el Mundial del 2026 se realizará en Estados Unidos, México y Canadá.
“Respaldo y confianza hay, sino yo no estaría aquí hoy, Evidentemente en el futbol universal dependen mucho los resultados para darle continuidad a un proceso, lo hablaba con respecto a Panamá que ha respaldado procesos más allá de sus resultados inmediatos”, concluyó.
Robinho tendrá que pagar su condena de nueve años en Brasil
AGENCIAS ESTO
Con once magistrados a favor y dos en contra. Un alto tribunal brasileño dio a conocer que exdelantero Robinho pague su condena de nueve años de prisión que fue emitida en Italia.
Dos se pronunciaron en contra de homologar la sentencia de la justicia italiana. Justo el mismo día en que otro jugador brasileño, Dani Alves, fue autorizado a salir de prisión en España, donde fue condenado por violación.
Los jueces del STJ decidieron además que Robson de Souza, conocido como Robinho, de 40 años, debe pagar la pena de “inmediato”.
El exfutbolista del Real Madrid reside actualmente en Santos y no compareció a la sesión, que tuvo lugar en Brasilia.
Defiende su inocencia al alegar que fueron consensuados los hechos por los que fue condenado en primera instancia en 2017: violar en grupo a una joven albanesa que celebraba su cumpleaños 23 en una discoteca de Milán.
La sentencia fue ratificada en 2022, cuando ya estaba radicado en Brasil.
Frente a la decisión judicial caben recursos, explicó a la AFP el abogado penalista Leonardo Pantaleão.
“Probablemente mañana va a ser expedido un oficio para que la justicia federal de Santos emita la orden de detención. Puede pasar que mañana mismo la defensa interponga un habeas corpus en la corte suprema y logre derrumbar” la decisión de prisión inmediata, agregó.
BRASIL NO EXTRADITA A SUS CIUDADANOS POR LO CUAL ROBInho NO SALDRÁ DEL PAÍS
La justicia italiana pidió el año pasado la ejecución de la pena aprovechando una ley brasileña que lo permite desde 2017.
El STJ examinó este miércoles apenas el pedido de homologación, sin entrar en el fondo del asunto ni juzgarlo de nuevo.


El reto será romper la hegemonía que el continente americano tiene en esta justa desde el 2004.
Desde entonces Argentina en un par de
ocasiones, México y Brasil en dos ocasiones fueron los que se coronaron.
Los Grupos del futbol varonil en París 2024
El torneo olímpico varonil está conformado por 16 selecciones nacionales que se dividirán en cuatro grupos con la misma cantidad de jugadores.
A
Francia, Estados Unidos, ICP/AFC/CAF y Nueva Zelanda
B
Argentina, Marruecos, AFC 3 y Ucrania C
AFC 2, España,Egipto y República Dominicana
D
AFC 1, Paraguay, Mali y Israel Los grupos del futbol femenil en París 2024
En el caso del torneo femenino son 12 los equipos que participan, mismos que se dividen en tres grupos de cuatro equipos cada uno.
Jueves 21 de Marzo de 2024 14. DEPORTES | elheraldodetuxpan.com.mx |
GP de Australia, lugar donde Checo Pérez debutó en F1
AGENCIAS
ESTO
La temporada 2024 de la Fórmula Uno tendrá su primera visita a un circuito tradicional con el Gran Premio de Australia. Lugar que le trae recuerdos diversos a Checo Pérez al ser la pista donde debutó en el máximo circuito, pero donde solamente ha tenido un solo podio. El mexicano espera dar un buen rendimiento en Albert Park y que sea el impulso para eventualmente pelear por el campeonato.
“Siempre me recuerda que debuté aquí, mi primera carrera en la Fórmula Uno. Fue en realidad buena y realmente disfruté.
Tengo muchas ganas de seguir desarrollándome esta temporada y seguir haciendo un buen trabajo y, con suerte, luchar por la victoria. El coche se ha sentido competitivo hasta ahora, pero Albert Park es una prueba totalmente diferente para el RB20 y será interesante ver cómo nos comparamos”, dijo en entrevista con Red Bull.
Asimismo, Checo Pérez explicó
que ha trabajado junto a sus ingenieros y mecánicos en busca de ajustar el bólido lo mejor posible al reto que representa Australia. Uno distinto a los trazados de Bahréin y Arabia Saudita en cuanto a temperatura y velocidad.
“Hemos estado trabajando duro como equipo desde Arabia Saudita para mejorar algunas áreas que identificamos. Estoy deseando ver cómo podemos rendir con algunos cambios menores. Creo que la parrilla será muy competitiva este fin de semana, por lo que es importante que tengamos un buen desempeño en la clasificación para colocarnos en un lugar positivo el domingo. La carrera del año pasado aquí fue un poco loca” explicó.
COMPUESTOS BLANDOS, EL DESAFÍO DE VERSTAPPEN EN AUSTRALIA
El tricampeón del mundo, Max Verstappen, señaló que uno de los retos más importantes que tendrá durante el próximo Gran Premio de Australia será la respuesta de los compuestos de su monoplaza, ya que al ser más blandos que en 2023,
Jaime Lozano no tiene claro a su titular ante Panamá
AGENCIAS
ESTO
La polémica con la portería Tricolor continúa. Luis Ángel Malagón y Guillermo Ochoa están en una lucha constante por convencer a Jaime Lozano, entrenador nacional, de que son el mejor para alinear el jueves ante Panamá, pero fue el propio Jimmy el que metió en la ecuación a Julio González. El entrenador nacional recalcó que todavía no tiene claro quién será el titular, pero aplaudió el nivel de su tridente bajo palos.
“Estamos hablando de Memo, hablando de Malagón, del mismo Julio y de los que no están, que estuvieron en la lista. Creo que los tenemos pocos
días, pero tenemos tiempo para verlos y para tomar una decisión. El que sea de los tres que inicie el partido ante Panamá, seguramente que lo hará de muy buena forma”, dijo el DT de México.
LOS PORTEROS ESTÁN EN EL TRI POR SU NIVEL Jaime comenzó a hablar del hombre con más experiencia. Guillermo Ochoa se ha ganado el respeto del técnico gracias a lo que aporta a los jugadores nacionales dentro y fuera del terreno de juego.
“Yo no lo veo como respetar jerarquías, porque hay jugadores que te dan mucho más que una titularidad. Lo veo así, lo siento así, tengo que estar con ellos todo el tiempo, entrenando, en el vestidor, en el hotel, y


la estrategia de pits deberá cambiar para detener el desgaste al límite.
“Es un trazado de pista muy rápido, que requiere una buena combinación de velocidad en recta y un agarre decente en las curvas,
no solamente es un tema de lo que nos ha dado, sino de lo que nos sigue dando y nos puede seguir dando, entonces, el que esté bien, evidentemente, porque partimos de esto, que esté bien, que pase un buen momento, porque ayer lo comentamos en nuestra primera reunión que tuvimos todos, si están aquí, independientemente del momento que vive el club de algunos, es porque para mí están bien, están bastante bien y le pueden dar a la selección todavía mucho”.
Después se centró en Luis Ángel Malagón, un arquero al que conoce a la perfección.
“Malagón no me movió el tapete porque sé lo que me puede dar y es prácticamente eso. Es un portero que me ha tocado y es uno de los dos, para mi entender, o tres, que me ha tocado ver durante el proceso olímpico que más crecimiento ha tenido, sin duda alguna, porque empezó un proceso
por lo que se trata de encontrar ese punto medio. La reciente repavimentación ha hecho que la pista sea mucho más suave y divertida de conducir, así que estamos deseando que llegue. También tenemos com-
olímpico siendo el cuarto o el quinto y acabó siendo el uno de ese proceso”.
JAIME LOZANO DESTACA EL CRECIMIENTO DE MALAGÓN
Incluso, calificó al arquero del América como uno que todavía está lejos de alcanzar su mejor nivel. “En Juegos Olímpicos nos reforzamos con Memo y Malagón terminó siendo el dos. Pero Malagón no tiene techo porque lo he visto crecer, porque lo ha demostrado y porque tiene, me parece, las cosas muy claras. No es que me sorprendió, yo sé que con los ojos cerrados cuando Malagón esté en la portería va a responder como lo ha hecho, como lo hace en su equipo cada ocho días, que a una corta edad ha llegado un equipo también importante y le ha tocado salir campeón y parte fundamental de ese equipo y de buen paso que tiene y de que sigan peleando por hacer cosas importantes es también gracias a él”.

puestos más blandos en comparación con el año pasado, lo que hará que la estrategia sea un poco más complicada, pero con suerte significa que es mejor para competir con más paradas en boxes”, sentenció.

Fiscalía habría ordenado la detención de Luis Rubiales
AGENCIAS ESTO
La Fiscalía habría emitido una orden de detención contra Luis Rubiales, aseguraron varios medios españoles. De acuerdo con las versiones, todo se trata de presuntas irregularidades en la Real Federación Española de Futbol.
El día de hoy la casa del exmandatario del futbol español fue registrada por la Guardia Civil, sin embargo, Rubiales se encuentra en República Dominicana, país que no tiene tratado de extradición con España, por lo que esperan que vuelva de forma voluntaria a España.
La periodista Isabel Rábago habló con Luis Rubiales, quien se mostró sorprendido por la situación.
“Estoy absolutamente sorprendido por todo esto. Llevo meses trabajando aquí, en República Dominicana. Llevo más de un mes seguido. Y de hecho, mi familia se
iba a desplazar a pasar conmigo la Semana Santa”, narró la reportera. La RFEF cooperará con la investigación
Respecto a toda la situación con Luis Rubiales, la RFEF publicó un comunicado en el que aseguran que darán su colaboración a las autoridades para esclarecer el tema.
“La RFEF ha ofrecido hoy toda la colaboración a las Fuerzas y Cuerpos de Seguridad del Estado, así como a la Justicia, tras el registro de su sede; y ha apostado por una absoluta transparencia en la institución que dirige el fútbol en España. En este sentido, considera que se debe llegar hasta las últimas consecuencias en la investigación en marcha.
“La Federación muestra su profunda preocupación por los hechos ocurridos en el día de hoy y aboga por ofrecer toda la transparencia posible, haciendo honor a los valores que representa el fútbol y que deben defender sus dirigentes, debiendo ser un ejemplo para la sociedad”, cerró.
| elheraldodetuxpan.com.mx | Jueves 21 de Marzo de 2024 .15 DEPORTES

INE asegura integridad electoral
AGENCIAS MÈXICO
En este proceso electoral, el Instituto Nacional Electoral (INE) ha frenado la contratación o ha dado de baja a mil 442 personas que buscaban ser Supervisores Electorales (SE) o Capacitadores Asistentes Electorales (CAE), por estar afiliados a algún partido político; la mayoría era afín a Morena y aliados.
En las últimas semanas, la Comisión de Quejas y Denuncias ha frenado a estas personas de participar en el proceso para reclutar y capaci-
tar a quienes serán funcionarios de casilla.
De estos, 795 están afiliados a Morena; 69 al Partido Verde y 44 al Partido del Trabajo. Del lado de la oposición, 221 están afiliados al PRI; 175 al PRD; 39 al PAN y 99 a Movimiento Ciudadano.
Este miércoles, la comisión determinó que 83 personas más fueran dadas de baja, al tener evidencia de que, de manera preliminar, hubo una afiliación consentida con alguno de los partidos políticos.
Para participar como CAE o SE es un requisito no militar en ningún partido político ni
Cuauhtémoc debe separarse como gobernador
AGENCIAS MÈXICO
El gobernador de Morelos, Cuauhtémoc Blanco, deberá separarse del cargo para conservar su candidatura como diputado plurinominal por Morena, determinó la Sala Superior del Tribunal Electoral del Poder Judicial de la Federación (TEPJF).
Por mayoría, se consideró que sí hay un impedimento por su cargo, a pesar de haber sido postulado por el principio de representación proporcional.
El proyecto del magistrado Felipe de la Mata planteaba confirmar su candidatura, al considerar que la restricción constitucional de no separarse del cargo aplica para el caso de la postulación de una diputación en la entidad federativa en la que se ejerce el cargo, es decir, para diputaciones de mayoría
haber participado activamente en campaña electoral en el último año previo a la difusión de la convocatoria.
El proyecto de la comisión apuntó que las personas consintieron de manera previa su inscripción como militantes de partidos políticos.
Expuso que existen cédulas originales de afiliación aportadas por los partidos políticos señalados como responsables o bien, cédulas electrónicas avaladas como válidas por la Dirección Ejecutiva del Registro Federal de Electores del INE, que contienen firma autógrafa de los ciudadanos.
México, país más feliz de Latinoamérica
AGENCIAS MÈXICO
México se ubica en el puesto 25 como el país más feliz de Latinoamérica, de acuerdo al Informe Mundial de la Felicidad 2024.
En el otro extremo está Afganistán, el país más infeliz del mundo, en el puesto 143 de 143 países encuestados.
El estudio basado en encuestas realizadas en 143 países, muestra que el territorio mexicano es el mejor situado en su rubro ya que Uruguay se ubica en el 26; le siguen El Salvador (33), Chile (38), Panamá (39), Guatemala (42), Nicaragua (43), Brasil (44), Argentina (48), Paraguay (57) Honduras (61), Perú (68), República Dominicana (69), Bolivia (73), Ecuador (74), Colombia (78) y Venezuela (79).
“La tendencia global positiva en la satisfacción vital entre las edades de 15 a 24 años acabó con la pandemia del coronavirus”, señala el estudio, fruto de una colaboración entre Gallup, el Oxford Wellbeing Research Centre, la Red de Soluciones para el Desarrollo Sostenible de la ONU y el Consejo Editorial del Informe Mundial de la Felicidad (WHR por sus siglas en inglés).
El informe también revela que Estados Unidos cae por primera vez en más de una década del ‘top 20’ de los países más felices del mundo impulsado, especialmente, por la bajada en la percepción de la felicidad de sus jóvenes.
El Informe Mundial de la Felicidad 2024 lo sitúa en el puesto 23, mientras que en la edición del año pasado ocupaba el 15.
El documento relaciona en parte el descenso de posiciones de EU, al igual que el de Alemania (puesto 24), a la tendencia a un aumento de la percepción de felicidad entre los países del Este de Europa.
Por el contrario, la felicidad en todas las edades ha aumentado marcadamente en Europa central y oriental, de modo que “los jóvenes ahora son igualmente felices en ambos partes de Europa”.
En los países de la exUnión Soviética y en Asia oriental también se han producido grandes aumentos en la felicidad a todas las edades, mientras que, en el sur de Asia y Oriente Medio y el Norte de África, por el contrario, ha caído.
España, en 2021 estaba en el puesto 24, en 2022 en el 29 y en 2023 en el 32; pasa al 36 en 2024.


relativa. Sin embargo, fue rechazado por tres magistraturas. A propuesta del magistrado Reyes Rodríguez Mondragón, se planteó que
Cuauhtémoc Blanco debe separarse del cargo porque es titular de la fuerza pública del estado y es un requisito para que conserve la candidatura.
“Se le debe exigir la separación inmediata del cargo a la gubernatura para cumplir con el requisito de la fracción cuarta que tutela la equidad de la contienda, es decir, que la posición que tiene como gobernador y ejercicio de la fuerza pública y otra serie de prerrogativas y facultades no lo pongan en una situación de ventaja o injerencia”, apuntó. La magistrada presidenta, Mónica Soto, sostuvo que aun cuando las diputaciones y senadurías se eligen por las listas de circunscripciones, la influencia de los titulares de gubernaturas sí podría incidir en el estado en el que gobiernan.
“Si la finalidad de la prohibición constitucional es inhibir cualquier intervención o intento de ella por parte de los titulares de las gubernaturas en las elecciones para las diputaciones federales y senadurías, por las repercusiones que ello podría tener en la voluntad de la ciudadanía, la equidad en la contienda y el intento de mantenerse en el poder, me parece que la norma no puede interpretarse en un sentido distinto”, subrayó. La magistrada Janine Otálora acompañó la propuesta, a favor de que se separe del cargo como gobernador de Morelos.
| elheraldodetuxpan.com.mx | Jueves 21 de Marzo de 2024 16. NACIONAL
Diputada irrumpe en tribuna
AGENCIAS MÈXICO
De manera sorpresiva, la diputada transgénero de Morena, Maria Clemente García, se subió al pleno y tomó la campana de inicio de sesión para interrumpirla, previo a la solicitud de licencia de la diputada Aleida Alavez Ruiz, debido a que no se ha aprobado la iniciativa de reforma sobre terapias de reconversión.
Mientras la secretaria de la Mesa Directiva, Estefanía Gutiérrez, del Partido Acción Nacional (PAN), iniciaba con la solicitud de licencia, se dio la interrupción de la legisladora quien gritaba “Se clausura la sesión por homofobia, por transfobia por lesbofobia, se clausura la sesión”.
García Moreno denunció que no se tomó en cuenta para la sesión de hoy, la iniciativa de terapias de reconversión que, dijo, ha sido pospuesta en varias ocasiones, lo que da cuenta del poco interés que tienen los
grupos parlamentarios en este tema.
Marcela Guerra abandona el pleno
Después de dialogar por varios minutos con la Presidenta de la Mesa Directiva de la Cámara, Marcela Guerra, la legisladora de Morena abandonó el pleno y en entrevista llamó a no votar ni por Claudia Sheinbaum ni por Xóchitl Gálvez.
“Que anulen su voto por la acción LGBTTTI, porque ni la derecha ni la izquierda los quiere, solamente nos utiliza y la muestra más clara somos Salma Luévano y yo, que estamos solamente siendo utilizadas para tener una cara de decir hay que hay dos personas trans pero no hay derechos para las personas trans”, comentó.
Indicó que, la semana pasada se comprometieron a que este miércoles se iba a discutir dicha iniciativa, pero no apareció en el orden del día, pero no cumplieron.
Marcela Guerra se vio obligada a decretar un rece -

so para dialogar con la diputada trans, y tras unos minutos, se trasladaron hasta la bancada morenista donde dialogaron con el coordina-

Tlaxcala registra fallecimiento por Guillain-Barré
AGENCIAS MÈXICO
Tlaxcala registró la primera muerte por el síndrome de Guillain-Barré, ocurrió el pasado 16 de marzo en el Hospital General del Instituto Mexicano del Seguro Social (IMSS) de La Loma Xicohténcatl. Además, en la entidad ya hay 26 casos positivos y otros 40 sospechosos, en espera de ser confirmados. “Hay 66 pacientes con síndrome de parálisis flácida aguda, de los cuales tenemos 26 positivos a síndrome de Guillain-Barré. Tenemos una defunción. Es un masculino de 48 años; actualmente, solo tenemos dos niños hospitalizados, tenemos 11 pacientes hospitalizados en estado de gravedad”, informó el secretario de Salud local,
Rigoberto Zamudio. De los 60 municipios que tiene el estado, en 25 se han detectado pacientes positivos con el síndrome de Guillain-Barré y fue Ixtenco el lugar en el que se presentó el primer caso. De acuerdo con el titular de salud del estado, la única relación que hay entre los que se han contagiado es el consumo de pollo contaminado. Por esta razón, verificadores de la Comisión Estatal Para la Protección Contra Riesgos Sanitarios del Estado de Tlaxcala se han dado a la tarea de supervisar, desde el pasado 8 de marzo, distintas pollerías con el fin de identificar el origen de la enfermedad. Según la COEPRIS, de todas las pollerías que verificaron, en 35 detectaron la presencia de la bacteria Campylobacter jejuni, causante del síndrome.
dor Ignacio Mier y el vicecoordinador Leonel Godoy con quienes se llegó a un acuerdo.
El coordinador de la ban-
cada de Morena, aseguró después en entrevista que el dictamen de las terapias de conversión se subirá al pleno el viernes para su discusión.
Profeco inicia Operativo Vacacional
AGENCIAS MÈXICO
Para el próximo período vacacional de Semana Santa, la Procuraduría Federal del Consumidor (Profeco) inició un operativo por el que vigilará que se respeten los derechos del consumidor y haya mayor conciencia de los compradores de hacerlos valer.
El director de la Profeco, David Aguilar Romero, dio el banderazo de salida del Operativo Vacacional de Semana Santa 2024, el cual dijo se extenderá del 20 de marzo al 7 de abril.
Durante ese tiempo se pondrán módulos de atención a los consumidores en aeropuertos, centrales de autobús, además de que se realizarán visitas de verificación a lugares vacacionales, hoteles y restaurantes.
“El Operativo Vacacional y Turístico incluye vigilancia y verificación en hoteles, balnearios, restaurantes, bares, líneas aéreas, centrales camioneras y agencias de viaje, con el apoyo de aproximadamente 300 servidores públicos de las Oficinas de Defensa del Consumidor en 38 ciudades”, dijo.
Comentó que en 2023 se dieron 13 mil 600 asesorías y se conciliaron 763 reclamaciones de forma exprés, sin mediar queja.
Para este 2024 se cuenta con módulos permanentes de atención en el Aeropuerto Internacional de la Ciudad de México en las terminales 1 y 2; en el Aeropuerto Internacional Felipe Ángeles (AIFA); en Tulum, en Cancún, y a partir de este periodo, también habrá en
Guadalajara.
Habrá también módulos temporales, de las 7 de la mañana a las 9 de la noche, en los aeropuertos de Mérida, Querétaro, Guanajuato, Villahermosa, Puerto Vallarta, Monterrey, Tijuana, Los Cabos y Toluca.
En la Ciudad de México se instalarán módulos de atención en las centrales camioneras: la Norte, la Poniente, en Observatorio; la Sur (Taxqueña) y Oriente (Tapo).
Mientras que, en el interior del país la Profeco instalará 11 módulos en las terminales de autobuses de Cancún, Mérida, Puebla, Querétaro, Guanajuato, Guadalajara, Tlaquepaque, Tepic, Monterrey, Tijuana y Villahermosa.
Tanto las básculas de aeropuertos y terminales de autobuses se calibraron y verificando “para que haya certeza en el peso y cobro de equipajes”.
Los consumidores pueden presentar sus quejas vía la conciliación inmediata por Conciliaexprés, al teléfono del 55 55 68 87 22, con las principales aerolíneas y líneas de autobuses del país.

| elheraldodetuxpan.com.mx | Jueves 21 de Marzo de 2024 .17NACIONAL
Tormenta deja muerto en Buenos Aires
AGENCIAS ARGENTINA
Un intenso temporal de lluvia y viento causó en Buenos Aires y localidades cercanas la suspensión de decenas de vuelos, inundaciones en viviendas, voladuras de techos y cortes de luz.
Al inicio de la tormenta en la noche del martes una mujer de 74 años falleció al ser golpeada por la baranda de un balcón que se desprendió del noveno piso de un edificio en una calle céntrica de la capital, indicó el Sistema de Atención Médica de Emergencias (SAME).
En los dos aeropuertos de Buenos Aires rigen alertas rojas debido a la actividad eléctrica y se suspendieron de manera temporal las actividades.
Distintas edificaciones resultaron inundadas por las fuertes correntadas de agua producto de las lluvias. Gran parte de la sede del club argentino de fútbol Racing Club, al sur de la capital, se encontraban anegadas.
Además, más de 76 mil usuarios se encontraban sin servicio eléctrico esta mañana en el área metropolitana de Buenos Aires, según el ente regulador de la electricidad.
En la provincia de Buenos Aires, la ciudad de La Plata, unos 70 kilómetros al sur de la capital, fue uno de los distritos más afec -

tados por las ráfagas de viento y la caída de granizo. Varias escuelas tuvieron que suspender el dictado de clases.
El Servicio Meteorológico Nacional emitió un alerta de tormentas fuertes para los distritos de Buenos Aires, La Pampa, Santa Fe, Entre Ríos y Córdoba, en el centro y este del país.
La alerta naranja por tormenta (que alcanza al este de Argentina en las provincias de Buenos Aires, Santa Fe, Entre Ríos, Córdoba y La Pampa) se refiere a fenómenos que pueden ser peligrosos para la sociedad, la vida, los bienes y

el medio ambiente; en tanto, la amarilla por viento (que abarca casi todo el país, salvo los extremos norte y sur) supone la interrupción momentánea de actividades cotidianas.
La zona noreste y este de Argentina viene siendo afectada desde hace días por fuertes lluvias en plena temporada del fenómeno climatológico de El Niño.
Las intensas lluvias que cayeron la semana pasada en la capital y el conurbano bonaerense causaron la muerte de un hombre, cortes de luz en miles de viviendas y la caída de árboles.

Alerta sanitaria en Japón
AGENCIAS JAPÓN
Una infección bacteriana aguda conocida por su progreso rápido y elevada tasa de letalidad, ha encendido las alarmas en Japón, ya que, la mayoría de los infectados no presentan síntomas, o solo experimentan dolor de garganta e infecciones cutáneas.
El síndrome de choque tóxico estreptocócico, causado en la mayoría de los casos por la bacteria denominada estreptococo del grupo A, alcanzó una cifra récord en 2023 con 941 casos en el país asiático y en lo que va del año suman 378 infecciones hasta el 25 de febrero.
La bacteria también conocida como “enfermedad carnívora” puede causar necrosis de los tejidos que recubren los músculos y, aunque se pueden infectar personas de todas las edades, la media es entre mayores de 30 años, según el Instituto Nacional de Enfermedades Infecciosas (NIID).
¿Qué síntomas provoca la infección de estreptococo?
Las personas infectadas por estreptococos no presentan síntomas, pero pueden padecer de dolor de garganta e infecciones cutáneas, en raros casos, la bacteria llega al torrente sanguíneo, los músculos y los pulmones.
Los síntomas pueden agravarse rápidamente y causar hipotensión arterial, fallo multiorgánico e incluso, en los casos más extremos, la muerte, según las autoridades japonesas, revela The Japan Times.
El Ministerio de Sanidad de Japón reclamó a los gobiernos locales que tomen muestras a los pacientes diagnosticados con la infección para determinar las cepas. Pero cualquier infección por estreptococos del grupo A puede evolucionar a síndrome de choque tóxico.
Facebook presenta fallas nuevamente
AGENCIAS ESTADOS UNIDOS
Facebook e Instagram presentan fallas la mañana de este miércoles 20 de marzo. Los primeros reportes de los usuarios comenzaron alrededor de las 09:00 horas.
Algunos problemas también se han extendido a las otras propiedades de Meta, es decir, a WhatsApp y Messenger, de acuerdo con una consulta realizada al sitio Downdetector.
El 5 de marzo pasado, las redes sociales mencionadas también sufrieron
toda clase de imprevistos por algunas horas, lo que provocó que los representantes de las mismas ofrecieran una explicación. Todo se redujo a un problema técnico, en realidad.
En Estados Unidos, el pico de reportes sobre Facebook, alrededor de 2 mil, se presentó a las 09:24 de esta mañana. En México, a las 09:12 horas, con alrededor de 500 reportes.
Downdetector, por ahora, no resalta complicaciones en otras plataformas sociodigitales, como sí se presentaron el 5 de marzo pasado, como un “efecto dominó”.
Eso sí, los usuarios están recurriendo a Twitter para dar sus impresiones sobre los imprevistos. De hecho, la etiqueta “Facebook e Instagram” se posicionó como tendencia alrededor de las 11:00 horas.
Los memes también comenzaron a surgir rápidamente. Se resaltó el hecho del protagonismo que adquiere X (anteriormente Twitter) en una situación así.
Alrededor de las 11:15 horas, los reportes bajaron considerablemente. En Facebook a esta hora, por ejemplo, ya era posible ver nuevamente las historias.
| elheraldodetuxpan.com.mx | Jueves 21 de Marzo de 2024 18. INTERNACIONAL

| elheraldodetuxpan.com.mx | Jueves 21 de Marzo de 2024 .19 COMERCIAL
Flores amarillas: Por qué se regalan el 21 de marzo
Entérate cómo una canción de hace casi 20 años tiene un papel importante en esta tendencia.
Desde hace varios años, gracias a las redes sociales, se hizo tendencia regalar flores amarillas el 21 de marzo, convirtiéndolo en una tradición para celebrar la llegada de la primavera y una gran excusa para regalar un detalle a tu persona especial.
Las flores amarillas permanecen en las principales tendencias de México; su fuerza es tal debido a que en pocas horas, específicamente el martes 21 de marzo llegará el equinoccio de primavera, fenómeno que da la bienvenida a esta estación del año y que tiene relación con una conocida canción a nivel internacional y nacional, alcanzando una gran popularidad.
¿CÓMO SE ORIGINÓ LA COSTUMBRE DE REGALAR FLORES EL 21 DE MARZO?
Las flores amarillas volvieron a ser tendencia, gracias a las redes sociales. Su popularidad en TikTok nació de la canción “Flores amarillas” de Floricienta, en la que cuenta que su sueño desde niña era que le regalen flores amarillas.
La canción es de 2004, pero ha retornado con fuerza gracias porque en las redes sociales las personas utilizan este audio para pedir que las personas que regalen flores amarillas en el día que marca el inicio de la primavera.
El significado, en concreto, es que el obsequio se da como una muestra de amor en la pareja y cumplir la fantasía de niñas o que quiere que pasen la vida juntos y que no pierdan más el tiempo, como pasa en esa novela con los personajes.
Los motivos por los que se regalan flores amarillas en México
La tendencia de TikTok refiere a que justamente la canción de “Flores amarillas” hay un párrafo en el que cuenta cómo es que “Floricienta” desde niña su sueño siempre ha sido que le regalen flores amarillas, así que la producción de



la novela argentina y sus miles de seguidores se encargaron de hacer tendencia esta historia.
La más reciente tendencia de TikTok esta enfocada a todas las parejas sentimentales, quienes deberán regalarse flores amarillas con el objetivo de expresar el amor que se tienen entre sí, y aparentemente cumplir aquel sueño de “Floricienta”, personaje de la novela argentina que hablaría por millones de mujeres y también hombres.
¿Cuál es la razón por la que en México se regalan flores amarillas?
A raíz de la tendencia que nació en la red social de TikTok, muchas parejas y personas regalan flores amarillas durante el mes de marzo. En México se volvió popular realizar esta acción con seres queridos y desconocidos, toda vez, que el día en que se extiende el regalarlas es el 21 de marzo, fecha en el calendario que indica la llegada de la primavera y mediante las cuales se obsequian para darle la bienvenida a esta etapa con una actitud positiva.
Otros países donde también se com-
parte la tendencia es en Argentina, Chile, Bolivia, Perú, Paraguay, Uruguay, así como Brasil y Ecuador, pero se acostumbra a que se regalen el 21 de septiembre.
Los datos del significado de regalar flores amarillas
Muchas personas han comentados en redes sociales que las flores amarillas tienen dos distintos significados y es que el obsequiarlas a las personas que se aman sentimentalmente adquiere un significado de amor, una vida juntos, y muchas otras características que incluso siguen relacionadas con la letra de la canción de la novela argentina “Floricienta”.
El segundo significado que se le atribuye especialmente al color amarillo, es que corresponde a los lazos de amistad, el reconocimientos de logros personales y profesionales e incluso está relacionado con la felicidad de las personas y el festejo de vivir cada día, sin embargo, al final cada persona decide en qué creer y como atribuir los significados a cada cosa o en este especial acaso a la nueva tendencia en Tiktok.
¿Qué significa regalar flores amarillas?
El significado de regalar flores amarillas puede variar según el contexto cultural y la ocasión. A continuación, te presentamos algunos posibles significados asociados con las flores amarillas:
Alegría y felicidad: El color amarillo está frecuentemente asociado con la alegría, la felicidad y la energía positiva. Regalar flores amarillas puede transmitir estos sentimientos a la persona receptora, expresando deseos de bienestar y optimismo.
Amistad y cercanía: Las flores amarillas también pueden simbolizar la amistad, la camaradería y la cercanía emocional. Son un regalo apropiado para mostrar aprecio y afecto hacia amigos y seres queridos, fortaleciendo los lazos afectivos.
Optimismo y esperanza: El color

amarillo se asocia frecuentemente con el optimismo y la esperanza. Regalar flores amarillas puede ser una manera de brindar ánimo y aliento a alguien que esté pasando por momentos difíciles, transmitiendo la idea de un futuro prometedor y lleno de posibilidades.
Apoyo y solidaridad: En algunas ocasiones, regalar flores amarillas puede ser un gesto de apoyo y solidaridad hacia alguien que esté atravesando dificultades o desafíos. Representa el respaldo emocional y la disposición para acompañar en momentos difíciles.
Es importante tener en cuenta que el significado de las flores puede variar según el contexto cultural y las costumbres locales. Por lo tanto, es recomendable considerar el contexto y la relación con la persona receptora al elegir flores amarillas como regalo.
Tipos de flores amarillas para regalar el 21 de marzo:
Tulipanes amarillos, Mimosa amarillas, Lirio amarillo, Narcisos amarillos, Margarita de flores amarillas, Gazania, Gerbera, Retama, Rosas amarillas, Gladiolos amarillos, Fresias amarillas, Flor canaria, Orquídeas amarillas, Verbena amarilla, Kerria, Petunia amarilla, Crisantemo.

| elheraldodetuxpan.com.mx | Jueves 21 de Marzo de 2024 20. DE INTERÉS


¡SE ACCIDENTA!
Por manejar a exceso de velocidad, motorista pierde el control en una curva y derrapa
REDACCIÒN MARTÍNEZ DE LA TORRE, VER.
Con heridas abrasivas, golpes contusos y probable fractura, ingresó a la sala de urgencias del hospital IMSS-Bienestar, niño que derrapó con su motocicleta.
El accidente ocurrió cerca de
las 14:00 horas sobre la carretera estatal que conduce a las comunidades Salvador Díaz Mirón-La Palma, por dónde un menor de edad que circulaba a bordo de su motocicleta y fue en una carretera donde perdió el control y terminó por derrapar sobre la carpeta asfáltica, para terminar fuera de la

¡La atropellan!
REDACCIÒN
MARTÍNEZ DE LA TORRE, VER.
Fémina ingresó a la sala del hospital IMSS-Bienestar, luego de ser atropellada por un automóvil por la báscula San Manuel, autoridades tomaron conocimiento.
María del Carmen, de 38 años de edad y vecina del municipio de Tlapacoyan, en su primer día de trabajo en una fonda ubicada en la báscula de San Manuel, fue atropellada por un vehículo en movimiento.
De acuerdo a la versión de personas de esta central de abastos, la unidad responsable se trata de un auto
carretera.
Una versión es que presumiblemente se estrelló en otra motocicleta, aunque no se encontraron indicios de tal declaración.
Fueron personas que circulaban sobre este tramo quienes encontraron la moto tirada en la cinta asfáltica y al bajar a ins-
peccionar el lugar encontraron al niño gravemente herido tirado sobre la hierba fuera de la carretera.
Fueron técnicos en urgencias médicas de la Cruz Roja Mexicana, quiénes llegaron hasta el lugar para brindar la atención prehospitalaria al menor y posteriormente tras-

de la marca Nissan, tipo Sentra, de color rojo, el cual al pasar exceso de velocidad por ese lugar, impactó a la femenina y tras dejarla lesionada se dio a la fuga.
Al sitio acudieron elementos de la Policía Preventiva Municipal y oficiales de la Guardia Nacional, se cerró la circulación por ese tramo y se solicitó la presencia de una ambulancia.
Al sitio arriba una ambulancia de Cruz Ámbar, quiénes hicieron cargo de brindarle la atención prehospitalaria. Cabe mencionar que el personal de Protección Civil, acudió minutos antes y atendieron a la víctima.
Con lesiones en cabeza, golpes contusos y heridas abrasivas, fue trasladada al hospital IMSS bienestar, dónde ingresó a la sala de urgencias.
ladarlo al hospital IMSS IMSSBienestar, dónde ingresó a la sala de urgencia, para ser valorado por un médico y diagnosticarle sus lesiones.
Mientras tanto las autoridades de vialidad serán las que inicien las indagatorias en cuanto a dicho accidente y determinen como ocurrió.

| elheraldodetuxpan.com.mx | Jueves 21 de Marzo de 2024 .21 POLICÍACA

¡Encontronazo!
Una persona muerta y otras más lesionada, deja choque de frente entra dos motocicletas
REDACCIÒN EMILIANO ZAPATA, VER.
El pan de cada día son los accidentes en moto, sin embargo, los conductores no toman las precauciones necesarias, y la mañana de este miércoles, un hombre falleció tras impactarse de frente y otro más quedó con severas lesiones; los hechos ocurrieron en la carretera Lencero-Tinaja del municipio de Emiliano Zapata.
Personas que pasaban por el sitio solicitaron ayuda a emergencias y llegaron elementos policiacos, así como ambulancias para atender a los lesionados, sin embargo, uno de ellos ya no contaba con vida.
Los paramédicos de Protección Civil Municipal, así como elementos de Fuerza Civil y Policía Estatal llegaron al punto luego de recibir el reporte del percance, en este tramo carretero, cuyo accidente sucedió poco después de las 8 de la mañana.
Capturan a asaltante
REDACCIÒN
PAPANTLA, VER.

De acuerdo con los primeros datos, se dio a conocer que una de las motos era conducida por un adulto mayor, quien perdió la vida de forma inmediata al chocar de frente con el otro conductor, quien quedó gravemente lesionado y fue trasladado a
Detienen a militar activo, presuntamente sería uno de los asaltantes de El Gigante de los Azulejos, hecho ocurrido la mañana del martes; al momento de su detención le decomisaron 800 dosis una sustancia parecida al cristal.
Fueron elementos de la Policía Municipal de Papantla, quienes lograron la detención de un hombre, en las inmediaciones del parque temáti-
un hospital de la capital. El lugar fue acordonado, en tanto personal pericial realizó las diligencias de ley, en tanto esperaban que llegara personal de la fiscalía para el levantamiento del cuerpo de la persona fallecida.

co Takilhsukut, donde caminaba, sin embargo, al notar la presencia de los uniformados este intentó huir a toda prisa.
Asaltan a pasajeros
REDACCIÒN IXTACZOQUITLÁN, VER.
Haciéndose pasar por viajeros, sujetos desconocidos con armas cortas asaltaron y despojaron de sus pertenencias a cerca de 40 pasajeros y al conductor del camión de pasaje foráneo de la Línea Plateados, cuando circulaba sobre la Autopista 150D Orizaba- Córdoba a la altura del municipio de Ixtaczoquitlán.
Durante su escape los presuntos asaltantes realizaron varias detonaciones de arma de fuego en contra del autobús, afortunadamente ninguna persona resultó lesionada, únicamente algunas mujeres presentaron crisis nerviosa.
Mediante un vídeo de las cámaras de seguridad instaladas dentro del camión de pasaje con una duración de 5 minutos con 21 segundos, se observa el robo masivo que se registró durante la noche de ayer martes sobre el tramo carretero Orizaba- IxtaczoquitlánFortín, justo entre los kilómetros 276 al 284 de la vía rápida 2100.
En él se observa como decenas de viajeros abordan el camión de pasaje de la Línea Plateados para trasladarse a sus domicilios una vez que habían concluido su jornada laboral.
En el trayecto, se observa cómo dos presuntos delincuentes se levantan de sus asientos, sacan sus armas de fuego, some-
ten y le quitan todo el dinero en efectivo de la cuenta del día al operador del autobús, mientras que otro asalta a los cerca de 40 pasajeros, quitándoles su dinero en efectivo, equipos de telefonía celular y demás pertenencias de valor.
Casi dos minutos después, los presuntos asaltantes descienden de la unidad y se dan a la fuga con rumbo incierto, pero debido a que el camión detuvo su marcha y los pasajeros se asomaron para observar hacia dónde se dirigían los presuntos delincuentes, estos realizaron detonaciones de arma de fuego en contra del autobús por lo que los usuarios regresaron a sus asientos y pidieron al conductor continuará su marcha para evitar seguir siendo agredidos por los disparos de arma de fuego.
Tras el violento atraco, hasta dicho tramo carretero llegaron cuerpos de seguridad, los cuales implementaron un operativo de búsqueda y localización de los presuntos ladrones, aunque desafortunadamente los resultados fueron nulos.
Los usuarios y habitantes de la zona conurbada de Orizaba y Córdoba, han exigido al Gobierno Federal, Estatal y Municipal,reforzar la seguridad en este tramo carretero que se encuentra a merced de la delincuencia y con ello se garantice la integridad física de miles de personas que se trasladan de manera diaria a laborar.

Por lo anterior los uniformados le dieron alcance y procedieron revisarlo, encontrando entre sus pertenencias más de 800 dosis de una sustancia blanquecina con características similares a la droga conocida como cristal.
Asimismo, se percataron que sus características coinciden con la descripción dada por los empleados de la tienda comercial El Gigante de los Azulejos, la cual horas antes habían sido atracados por dos sujetos.
De trata de Jesús Rosalino “N”, de 22 años, quien se identificó con los uniformados como elemento activo de la Secretaría de la Defensa Nacional, desta-
camento en el estado de Puebla.
Este había quedado grabado por distintas cámaras de seguridad de varios negocios luego de atracar la tienda comercial antes mencionada, lo que se definirá tras las investigaciones a fondo.
Ante esta situación y señalamientos, el sujeto fue intervenido y trasladado a la Unidad Integral de Procuración de Justicia del Octavo Distrito Judicial, con la finalidad de ser debidamente procesado, y que las autoridades correspondientes inicien una carpeta de investigación para la responsabilidad que le resulte, y será un juez de Control quien determine su situación jurídica.
Jueves 21 de Marzo de 2024 22. POLICÍACA | elheraldodetuxpan.com.mx |


Percance vial
REDACCIÒN COTAXTLA
Aparatoso choque de frente, con salida de camino de ambos vehículos y donde uno de ellos, quedó con las llantas hacia arriba, ocurrió en el municipio de Cotaxtla.
El accidente se registró sobre el tramo carretero La TinajaPaso del Toro, entre las localidades El Rubí-La Esmeralda y La Candelaria.
Aquí protagonizaron este choque frontal una camioneta Volkswagen tipo Pointer, en color blanco y con placas de circulación HC-1621-G.
Así como, una camioneta con tubulares dedicada a transportar mercancía.
Uno de los conductores rea-
Procesan a asesino
REDACCIÒN VERACRUZ
lizó invasión de carril contrario y de esta manera, se produjo el percance vial.
Al lugar acudieron Paramédicos de Protección Civil Municipal de Cotaxtla y elementos de la Secretaria de Educación Pública de Veracruz.
Una vez que se le atendió a los conductores, se logró saber que nada era de gravedad en cuanto a las lesiones que sufrieron.
Un oficial de la Guardia Nacional División Caminos se encargó de realizar el deslinde de responsabilidades correspondientes.
Los daños materiales fueron cuantiosos y con el apoyo de una grúa, ambas unidades fueron llevadas al encierro oficial de vehículos siniestrados.
El joven de 18 años Kevin Anderson “N”, detenido como sospechoso principal en la muerte del publirrelacionista Alfredo Alejandro Beauregard fue vinculado a proceso como probable responsable del delito de homicidio doloso calificado.
La Fiscalía General del Estado de Veracruz a través de sus redes sociales
su¡Desbarata vehículo!
Conductora de camioneta vuelca y rebota contra un árbol, luego de haber festejado su cumpleaños
REDACCIÒN VERACRUZ, VER.
La conductora de una camioneta sufrió una volcadura en la autopista Veracruz-Córdoba, luego de haber festejado su cumpleaños, manejar a presunto exceso de velocidad y en supuesto estado de ebriedad, siendo llevada por personal de Capufe al Hospital Regional de Alta Especialidad.
La mujer lesionada responde al nombre de Estefania V. C., de 24 años, quien iba a bordo de una Volkswagen Tiguan blanca, vehículo que en el kilómetro 96 se salió de la carpeta de rodamiento, cuando estaba a punto de llegar a Cabeza Olmeca, este miércoles por la tarde.
De acuerdo a las autoridades de la Guardia Nacional, la unidad siniestrada era manejada en posible exceso de velocidad, esto por la manera en que terminó la camioneta, ya que tras salirse de la carretera, rebotó contra un árbol a una altura de aproximadamente 5 metros de altura.
Elementos de Caminos y Puentes Federales arribaron al lugar con su unidad de emergencias para atender a la conductora, quien fue traslada al hospital para ser atendida, ya que presentaba lesiones qué requerían atención.
Autoridades procedieron con el abanderamiento y retiro de la unidad, destacando que de no ser por los sistemas de seguridad y el cinturón, la joven hubiera perdido la vida.

informó que la autoridad judicial emitió dicha vinculación a proceso en contra de Kevin Anderson “N” por los hechos cometidos en agravio de la víctima iden-


tificada como Alfredo Alejandro, que en su momento se dijo que era amigo de la influencer veracruzana Yeri MUA.
“El juez dictó como medida cautelar prisión preventiva justificada y 4 meses para la investigación complementaria, dentro del proceso penal 164/2024-B”, señaló la Fiscalía.
El lunes 11 de marzo el joven Alfredo Alejandro Beauregard, de 31 años de edad, fue hallado tirado en la calle con la playera llena de sangre y sin vida, de acuerdo a sus documentos tenía su domicilio en el fraccionamiento Los Pinos.
La víctima presentaba numerosas
puñaladas en la espalda y en las costillas; junto al cuerpo estaban las llaves de su vehículo, un Nissan tipo March de color blanco que estaba estacionado a unos metros de donde él cayó fulminado.
Ese mismo lunes 11 de marzo, el presunto culpable del crimen fue detenido junto con un menor de edad, también señalado por haber participado en el crimen de Alfredo Beauregard.
El miércoles 13 de marzo una jueza de control validó la detención de Kevin Anderson “N” por homicidio doloso, el cual se encuentra asentado en la carpeta de investigación 164/2024.
| elheraldodetuxpan.com.mx | Jueves 21 de Marzo de 2024 .23POLICÍACA
el Heraldo de Coatzacoalcos

Jueves 21 de Marz0 de 2024 24. ESPECIAL | elheraldodetuxpan.com.mx | 14. PRIMERA SECCIÓN Lunes 18 de Marzo de 2024 18. PRIMERA SECCIÓN Miércoles 06 de Septiembre de 2023
el Heraldo de Coatzacoalcos

Jueves 21 de Marz0 de 2024 .25 ESPECIAL | elheraldodetuxpan.com.mx | .15 PRIMERA SECCIÓN Lunes 18 de Marzo de 2024 .19 PRIMERA SECCIÓN Miércoles 06 de Septiembre de 2023

Jueves 21 de Marz0 de 2024 26. ESPECIAL | elheraldodetuxpan.com.mx | PRIMERA SECCIÓN Jueves 09 de Marzo de 2023 el Heraldo de Coatzacoalcos 16. PRIMERA SECCIÓN Lunes 18 de Marzo de 2024
el Heraldo de

Jueves 21 de Marz0 de 2024 .27 ESPECIAL | elheraldodetuxpan.com.mx | .17.21 PRIMERA SECCIÓN Jueves 09 de Marzo de 2023
Coatzacoalcos PRIMERA SECCIÓN Lunes 18 de Marzo de 2024
el Heraldo de Coatzacoalcos

Estudiar para cuidar el medio ambiente
Incluir temas ambientales en los programas de educación superior permitiría que universitarios y profesionistas aprendieran sobre la agenda ambiental que se desarrollará en los años siguientes y puedan, desde hoy, generar soluciones desde una perspectiva de responsabilidad ambiental y social.
EL
UNIVERSAL CIUDAD DE MÉXICO
Escuchar sobre los problemas ambientales se ha vuelto una constante en la última década. Los efectos causados por las variaciones climáticas se han comenzado a percibir en algunas partes del mundo. La Organización de las Naciones Unidas (ONU) ya ha estudiado algunas de las consecuencias, entre ellas, el incremento de la temperatura del planeta en cerca de 0.74°C durante el último siglo o el que distintas regiones del mundo presentan sequías importantes.
Pero los jóvenes hemos comenzado a entender su traición. Los ojos de las generaciones futuras están sobre ustedes y si deciden fallarnos, nunca los vamos a perdonar”, comentó Greta en su discurso frente a la Asamblea General de la ONU durante la Pasada Cumbre sobre la Acción Climática en Nueva York.
SUSANA LIZANO LA CIENCIA APOYAR EL DEL MUNDO’
Los jóvenes también son conscientes del problema y actúan en consecuencia. Muestra de ello son las distintas movilizaciones alrededor del mundo que los estudiantes realizan para exigir acciones certeras para frenar el avance del cambio climático. Si bien a lo largo de los años este tipo de manifestaciones se han llevado a cabo, en los meses recientes se han inspirado por la postura jóvenes como Greta Thunberg, quien ha confrontado a los líderes globales sobre sus insuficientes acciones en este tema.
Thunberg, una joven de 16 años, inició en su escuela, en Suecia, el movimiento Fridays for Future en el que un día a la semana no iba al colegio para dedicarse a manifestarse en contra de las decisiones tomadas para intentar solucionar los problemas ambientales. Desde su inicio en 2018, este movimiento se ha replicado en varias partes del mundo generando diversas conversaciones sobre las tareas que deberían llevarse a cabo.
Para discutir las posibles acciones, del 2 y al 13 de diciembre en Madrid, España, se llevará a cabo La Conferencia de la ONU sobre el Cambio Climático, COP25. Ahí se realizará la segunda reunión de las partes del Acuerdo de París firmado por 195 países en 2015 en el que se comprometieron a reducir las emisiones.
Para la astrofísica mexicana, la pandemia ha representado una gran oportunidad para acceder a la información científica desde sitios autorizados, evitando el amarillismo y las noticias falsas.
“La gente está sufriendo. La gente está muriendo y nuestros ecosistemas están colapsando. Estamos en el inicio de una extinción masiva y ustedes solo hablan de dinero y cuentos de hadas de crecimiento económico. ¡Cómo se atreven!… Ustedes nos están fallando.
Por la relevancia del tema, la ONU también ha planteado 17 Objetivos de Desarrollo Sostenible. En el número 13 plantea, como una de las soluciones, a la educación ya que esta puede lograr la sensibilización de la sociedad respecto de la mitigación de la crisis climática.
Jueves 21 de Marz0 de 2024 28. ESPECIAL | elheraldodetuxpan.com.mx | 18. 26.
Martes 20 de Abril de 2021 www.heraldodecoatzacoalcos.com.mx 10. EL HERALDODE COATZACOALCOS Jueves 09 de Enero 2020 heraldodecoatzacoalcos.com.mx 16. DE COATZACOALCOS Martes 03 de Diciembre 2019 heraldodecoatzacoalcos.com.mx 10. DE COATZACOALCOS
PRIMERA SECCIÓN Jueves 09 de Marzo de 2023
PRIMERA SECCIÓN Lunes 18 de Marzo de 2024
PRIMERA SECCIÓN
PRIMERA SECCIÓN
Jueves 09 de Marzo de 2023
Lunes 18 de Marzo de 2024
para ambiente
EDUCACIÓN CONTRA LA CRISIS CLIMÁTICA Incluir temas ambientales en los programas de educación superior permitiría que universitarios y profesionistas aprendieran sobre la agenda ambiental que se desarrollará en los años siguientes y puedan, desde hoy, generar soluciones desde una perspectiva de responsabilidad ambiental y social.
Y, aunque integrar materias o talleres para hacer consciencia del problema parece ser una solución, si se quiere lograr verdaderos cambios, es necesario revalorar el enfoque de la educación superior en general y darle una nueva visión que atienda las prácticas sostenibles.
“Adaptar nuestros sistemas de estudio es muy importante y probablemente sea la solución de fondo. No se trata de incluir los temas en clases como Ecología y que las demás materias se sigan impartiendo de la misma manera. Todas las especialidades deberían incorporar una visión ambiental para que se comience a pensar en solucionar los problemas desde los distintos oficios”, dijo Federico Llamas, Socio Fundador y Presidente del Consejo de la Universidad del Medio Ambiente (UMA).
La UMA, ubicada en Valle de Bravo, Estado de México, se distingue como una de las primeras opciones en América Latina con programas que preparan a los alumnos no solo con el enfoque de resolver problemas cotidianos y específicos de sus disciplinas, sino con una consciencia ambiental. La institución cuenta con una oferta de estudios de posgrado en áreas como Derecho, Arquitectura o Administración, todas con el respaldo temático sustentable.
“La UMA surge por la necesidad que hay en el país de contar con profesionistas en el tema ambiental. Actualmente contamos con siete maestrías, mismas que pueden estudiarse de modo semipresencial”, explicó Llamas.
Sin embargo, el que exista una universidad con estas características, opinó el
el Heraldo de Coatzacoalcos
CARRERAS CON UN NUEVO ENFOQUE
» DERECHO
En el área de Derecho, la especialidad Ambiental hace énfasis en el análisis de los recursos y las vías legales para llevar a cabo proyectos que sean sostenibles ambiental y socialmente.
Si bien ofrecen unidades temáticas que abarcan habilidades necesarias para la profesión como Investigación activa de proyectos, Pensamiento crítico o Argumentación legal, estas son mezcladas con conocimientos sobre el enfoque ambiental tales como Estructura de la regulación del medio ambiente, Justicia ambiental, Problemas sociambientales o Fundamentos de sostenibilidad.
» ¿DÓNDE ESTUDIAR?
Maestría: Derecho Ambiental y Política Pública Universidad del Medio Ambiente umamexico.com
Diplomado: Derecho del Cambio Climático y Gobernanza Universidad Nacional Autónoma de México www.juridicas. unam.mx
Seminario: Aplicación de la legislación ambiental Tecnológico de Monterrey maestriasy diplomados.tec. mx
Especialidad:
Derecho Ambiental Universidad Anáhuac www.anahuac. mx
Presidente del Consejo, refleja una falla en el sistema educativo debido a que los programas de otras instituciones no han considerado importante las materias ambientales y no han desarrollado una mayor oferta
» ARQUITECTURA
Hay programas de estudio enfocados en lograr estándares y certificaciones internacionales que permiten que los diseños arquitectónicos sean sustentables y generen un impacto mucho menor en los espacios donde son construidos.
En el caso de la Licenciatura en Arquitectura de la Universidad Intercontinental (UIC) buscan que los alumnos se certifiquen en LEED, norma que indica si un edificio es óptimo en cuanto a sostenibilidad, ahorro de recursos, seguridad y consciencia ambiental.
De igual manera, mezclan habilidades generales y materias para comprender conceptos como la sostenibilidad y que éstos sean aplicados día a día en sus profesiones.
» ¿DÓNDE ESTUDIAR?
Licenciatura: Arquitectura
Universidad Intercontinental www.uic.mx
Diplomado-taller: Métodos y procedimientos de certificación y normatividad para la edificación sustentable Universidad Nacional Autónoma de México arquitectura.unam.mx
Posgrado en línea: Crecimiento urbano, retos y soluciones: cómo lograr el uso sostenible del suelo urbano Tecnológico de Monterrey maestriasydiplomados. tec.mx
Diplomado: Arquitectura Bioclimática
Universidad Anáhuac Xalapa www.anahuac.mx
» ADMINISTRACIÓN Crear una empresa que sea responsable social y ambientalmente ya no solo es un tema de consciencia por parte de sus creadores, el impacto que puede generar una organización a su alrededor podría incluso influir en el éxito que esta pudiera tener en el futuro y su capacidad de adaptarse a las necesidades de sus segmentos de negocio.
Esta especialidad debe ser considerada por emprendedores, ejecutivos y consultores para que sean capaces de atender las distintas fases de desarrollo de una empresa con un enfoque integral hacia la responsabilidad ambiental y social.
» ¿DÓNDE ESTUDIAR?
Maestría: Administración de Empresas Socioambientales Universidad del Medio Ambiente umamexico.com
Especialidad en línea: Administración energética Tecnológico de Monterrey maestriasy diplomados.tec.mx Licenciatura: Administración Agropecuaria Universidad Nacional Autónoma de México enes.unam.mx
de especialidades. Es por ello que la UMA propone dar un nuevo enfoque a las carreras tradicionales. “Se ha trabajado en las universidades para generar nuevos planteamientos, pero creo que falta mucho por recorrer. Por ello nosotros, por ejemplo en el caso de Administración, analizamos las finanzas, pero desde el punto de vista de cómo se relacionan con el tema ambiental, de cómo influyen para generar un daño o una solución al pro-
» TURISMO
Las experiencias turísticas que no solo atienden la importancia y valor del legado cultural del país, sino que se responsabilizan de los impactos dentro de las comunidades y regiones donde se llevan a cabo, son cada vez más importantes para garantizar bienestar económico y entretenimiento, pero sin dañar los recursos naturales, logrando un cambio de visión o hábitos entre los visitantes.
Con este enfoque, el Turismo Sostenible se basa tanto en los fundamentos del turismo y en conceptos básicos de mercado, como en el estudio de las características de los diferentes lugares. Por ejemplo, en la República Mexicana podrían implementarse proyectos turísticos sostenibles que atiendan las diversas necesidades de viajeros y ecosistemas.
» ¿DÓNDE ESTUDIAR?
Maestría: Turismo Sostenible Universidad del Medio Ambiente umamexico.com/ maestria-en-turismosostenible
Maestría: Gestión de destinos turísticos Universidad Anáhuac www.anahuac.mx
Licenciatura: Turismo Instituto Politécnico Nacional www.est.ipn.mx
blema”, afirmó el directivo de la universidad.
Pero, como la creación de habilidades y consciencia que lleven a la búsqueda y aplicación de soluciones ambientales es mucho más complicada si se hace de manera individual, trabajar en conjunto debería ser la fórmula para generar un mayor impacto.
“Adaptar los planes de estudio es una cuestión de evolucionar o morir. No podemos desarrollar profesionistas sin consciencia ambiental clara. En nuestro caso ya no aplicamos este enfoque en las materias sino en retos que implican componentes disciplinarios transversales para enseñar a los
» INGENIERÍAS
Sectores como el energético requieren de profesionales especializados en fuentes limpias como la eólica, así como de ingenieros que puedan adaptar correctamente sistemas ya establecidos para funcionar de manera mucho más sustentable.
También es importante preparar a los estudiantes en las normas, regulaciones y teorías necesarias para desarrollar sus proyectos de un modo más eficiente.
» ¿DÓNDE ESTUDIAR?
Ingeniería: Energía y Desarrollo Sustentable Universidad del Valle de México uvm.mx
Ingeniería: Sistemas Ambientales Instituto Politécnico Nacional www.ipn.mx
Ingeniería: Energías renovables Benemérita Universidad Autónoma de Puebla www.buap.mx
alumnos a aplicar habilidades como la sostenibilidad, desde sus propias carreras”, dijo la doctora Laurence Bertoux, decana asociada de la Escuela de Arquitectura, Arte y Diseño del Tecnológico de Monterrey. Es así que integrar estas estrategias y enfoques no solo debiera implicar la creación de nuevas especializaciones, sino la actualización de los planes de estudio actualmente establecidos. Esta decisión debe darse a modo de reacción ante la situación ambiental que hoy se vive, añadiendo como ventaja que las nuevas generaciones están dispuestas a adquirir estos conocimientos.
Jueves 21 de Marz0 de 2024 .29 ESPECIAL | elheraldodetuxpan.com.mx | .19 .27 Martes 20 de Abril de 2021 www.heraldodecoatzacoalcos.com.mx .11 EL HERALDODE COATZACOALCOS Jueves 09 de Enero 2020 heraldodecoatzacoalcos.com.mx .17 DE COATZACOALCOS Martes 03 de Diciembre 2019 heraldodecoatzacoalcos.com.mx .11 DE COATZACOALCOS
PRIMERA SECCIÓN
Lunes 18 de Marzo de 2024
PASAJEROS PIERDEN POR MENOS VUELOS EN AICM: EXPERTOS
Esta reducción unilateral de operaciones implica un replanteamiento para las aerolíneas en sus planes de negocio y de la nómina en la Ciudad de México.
La reducción de operaciones en el Aeropuerto Internacional de la Ciudad de México (AICM), que pasará de 52 a 43 vuelos máximos por hora en franjas saturadas, afecta a las aerolíneas, pero se traducirá en menos disponibilidad de asientos y aumentos de precios para los pasajeros, dijeron expertos.
La semana pasada, el director general del AICM, Carlos Velázquez Tiscareño, explicó que las aerolíneas con el mayor número de slots son las que regresarán más horarios. Esto significa que las aerolíneas nacionales serán las más afectadas.
De acuerdo con especialistas, Aeroméxico tendría

que eliminar 39.3 vuelos diarios, el equivalente a 275.3 vuelos menos a la semana en la próxima temporada de invierno 2023.
Volaris tendría que dejar de operar 10.2 vuelos diarios, es decir, 71.6 a la semana, y Viva Aerobus tendría que eliminar 8.6 vuelos diarios o 60.5 vuelos a la semana.
IMPACTOS DIRECTOS
Juan Carlos Machorro, socio de la firma Santamarina y Steta y experto en derecho aeronáutico y aeroportuario, dijo que esta reducción unilateral de operaciones implica un replanteamiento para las aerolíneas en sus planes de negocio y de la nómina en la Ciudad de México.
“Podría haber algunos despidos y pérdidas económicas. Se habla de un impacto de 1.5 millones de pasajeros que se van a quedar con las ganas de volar en las vacaciones de diciembre”, advirtió.
Para los viajeros, el impacto será en varias áreas, detalló.
Por ejemplo, aquellos que habían adquirido boletos con anterioridad podrían ver cancelados sus vuelos y, cuando hay mucha demanda y se reduce la oferta, los precios suben. Además, detalló, se reduce la conectividad en ciudades de menor tamaño porque las aerolíneas se concentrarán en atender las rutas de mayor demanda.
PREVÉN AMPAROS
Rogelio Rodríguez, titular de posgrado de la cátedra de Derecho Aéreo y Espacial de la Facultad de Derecho de la UNAM, considera que lo más probable es que las aerolíneas se amparen cuando el Comité de Operación y Horarios del AICM no les apruebe su paquete de horarios para la temporada de invierno.
Ahí habría “actos de molestia”, agregó, lo que ocasionaría juicios de amparo tanto de aerolíneas nacionales y extranjeras.
En su opinión, las aerolíneas también pueden argumentar que Servicios a la Navegación en el Espacio Aéreo Mexicano (Seneam) no puede determinar la saturación de los edificios terminales, sino únicamente el espacio aéreo.
“Se rompe la justificación de la reducción de horarios en función del campo aéreo, porque ahora son los edificios terminales”, indicó.
Además, destacó que esta medida afecta económicamente a las aerolíneas, ya que el mercado consolidado está en la Ciudad de México y esto implica cancelar vuelos, replantear rutas hacia mercados donde

esas empresas van a arriesgar, porque no hay un pasaje seguro y tendrían que bajar tarifas.
“Todo esto implica perder un ingreso seguro en la mejor temporada del año, que es la de invierno”, apuntó Rodríguez.
“Perder esos vuelos es una merma que puede implicar recortes de personal y de servicios de terceros, etcétera. Es un golpe fuertísimo y menor oferta para el pasajero”.
DEBATE TÉCNICO
Machorro agregó que, desde el punto de vista regulatorio, las reglas de operación de la Asociación Internacional de Transporte Aéreo (IATA) indican que cualquier reducción de horarios se tiene que hacer con un año de anticipación.
“Hay que revisar muy bien la solidez de la argumentación por parte de la autoridad para bajar las operaciones. No está claro que los argumentos se sostengan desde un punto de vista técnico. Es posible que este argumento vaya a ser parte de lo que las aerolíneas utilicen en su defensa media-
te algún tipo de amparo”, adelantó Machorro.
TAMBIÉN LAS EXTRANJERAS
De acuerdo con el análisis de los expertos, las aerolíneas extranjeras también se verán afectadas.
United Airlines tendría que recortar 2.5 vuelos diarios o 17.6 vuelos menos a la semana, y American Airlines 2.2 vuelos al día o 15.2 semanales.
En tanto, Delta deberá olvidarse de 1.9 vuelos diarios, es decir, 13.3 vuelos por semana.
Air Canada tendría que pasar de 18 vuelos semanales a 12.7 vuelos; Air France reduciría su operación de 16.3 vuelos a la semana a sólo 11.5 vuelos, y Lufthansa tendría que reducir sus 10.5 rutas a la semana a sólo 7.4 vuelos.
Copa tendría que quitar un vuelo diario, lo que da como resultado pasar de 24.5 vuelos semanales a sólo 17.3; Lan Perú pasaría de siete vuelos a la semana a 4.9 vuelos.
En tanto, Emirates pasaría de siete vuelos a la semana pasaría a sólo 4.9 vuelos, lo mismo para British Airways y KLM.
Jueves 21 de Marz0 de 2024 30. ESPECIAL | elheraldodetuxpan.com.mx | 20. 24. MIÉRCOLES 06 DE SEPTIEMBRE DE 2023
EL UNIVERSAL CIUDAD DE MÉXICO
el Heraldo de Coatzacoalcos

Corvette C8 Z06, pasión en la pista
Desde ser un ícono de los modelos de colección a escala hasta presumirse como “el auto oficial de los astronautas”, el deportivo americano ha sido, y será, un tema serio dentro del mundo de los autos.
entorno. Miras la pista, sus curvas y trayectoria y sí te imaginas tratando de ir lo más rápido posible abordo del Z06.
Existen pocos nombres con tanto legado en la industria automotriz como el que puede presumir el Chevrolet Corvette. Desde ser un ícono de los modede colección a escala hasta presumirse como “el auto oficial de los astronautas”, deportivo americano ha sido, y será, un tema serio dentro del mundo de los autos. Naturamente, cuando se anunció su nueva generación de motor central, algupersonas comenzaron a criticar esta decisión. Sin embargo, con el paso de los años, ha demostrado ser una excelente solución para mezclar esa sensación de deportividad americana con el refinamiento y manejo de modelos europeos. Ahora Chevrolet trae a México la versión más radical del modelo al día de hoy: Z06. Si te suena el nombre es porque estado presente desde hace varias generaciones, y se caracteriza por ser la versión de alto desempeño del Corvette. Para ponerlo a prueba, Chevrolet organizó una tarde en México Drive Resort, pista nueva ubicada al poniente de CDMX, en donde pudimos conocer un poco más a detalle sus características. La idea del producto es colocarse a niveles un Porsche 911 GT3 o un Mercedes AMG GT. ¿Su punto fuerte? El precio.
HÁBITAT NATURAL
Llegamos a la cita y, esperándonos al centro de la pista, está el nuevo Corvette Z06. Desde el primer instante, nos damos cuenta que el auto no desentona con el
Antes de poner las manos al volante, y luego de una breve plática de producto, comienzo a ver los detalles que convierten a este Corvette en algo especial. Lo primero que sobresale es el gran alerón con formas afiladas.
Como era de esperarse de en un Z06, las cuatro salidas de escape centrales están presentes y, según Charlie Rusher (ingeniero de la marca responsable de los productos de alto desempeño), cada elemento aerodinámico que veamos en el auto tiene una función.
Desde entradas de aire más grandes al frente, hasta rines con un diseño que aminora la turbulencia a altas velocidades y el ya mencionado alerón, se nota que el Corvette Z06 fue pensado para exprimir cada segundo en la pista.
“¿Cuantas noches sin dormir tuviste que pasar para que nosotros pudieramos tener un buen rato en la pista?” le pregunto a Charlie. “¡Ja! Te sorprenderías… Es como llevar a tu bebé a la escuela. Sabes de lo que es capaz y cómo es, pero también quieres que le caiga bien a los demás y demuestre lo que sabe…”, responde el ingeniero de la marca con un tono de broma. El trabajo de Charlie y su equipo es notable a primera vista, pero la realidad es que se percibe mucho mejor cuando estás al volante.
DÓCIL, PERO AGRESIVO
Como todo auto deportivo de alto rendimiento, al ponerlo a prueba en una pista debes ir de menos a más para conocer el

límite sin arriesgarte. Luego de una vuelta de calentamiento, y reconocimeinto de pista, estamos listos para dar un par más a todo lo que den nuestras manos (y gónadas) en la complicada pista.
Arrancamos lentamente desde pits y, al salir, aceleramos a fondo. El motor V8 de 5.5 litros a nuestras espaldas emite un sonido fuera de lo común. Esperarías ese tono ronco de un V8 americano, pero es más alto y “refinado”.
Esto es, principalmente, por la modificación en el cigueñal, que ahora es plano. Al ser así, las vibraciones y frecuencias que se generan son diferentes y, como resultado, se puede llevar a más altas revoluciones y emitir un sonido que, realmente, puede ser confundido con un Ferrari.
La forma en la que tomas las curvas con relativa facilidad a altas velocidades solo te habla del excelente trabajo que realizó el departamento técnico de la marca. La suspensión es dura y el balanceo es casi nulo. Eso sí, si eres desesperado con el acelerador al salir de las curvas, es muy probable que termines con el coche mirando hacia la dirección contraria.
Frenar con contundencia antes
de las curvas es adictivo y, gracias a su potencia, puedes alargar la frenada hasta el último punto de referencia para comerle segundos al reloj. Entre otras cosas, sobresale que, al presionar el botón “Z” del volante, el auto se torna ligeramente más responsivo al acelerador, y la dirección se vuelve un poco más dura para mejorar la precisión.
El único punto que, por momentos, sentimos como algo a mejorar es el tema del torque a altas revoluciones. El auto te pide ser llevado arriba de las ocho mil RPM para que escuches ese escape de alto nivel, pero, cuando pasas las cinco mil RPM, parece dejar de empujar.
460 lb-pie de par y una transmisión de ocho velocidades podría sonar como una buena configuración, pero hay que recordar que es un motor atmosférico y, naturalmente, la altitud de la CDMX afecta su desempeño.
El Corvette Z06 estará disponible en pisos de venta seleccionados por 3.6 millones de pesos. Si bien suena a mucho dinero, por un desempeño similar en pista de algún rival europeo, fácilmente pagaríamos más de 4.5 millones de pesos.
Miércoles 20 de Marz0 de 2024 .31 ESPECIAL | elheraldodetuxpan.com.mx | .21 PRIMERA SECCIÓN Sábado 11 de Marzo de 2023 06. EL HERALDODE COATZACOALCOS
CIUDAD DE MÉXICO
UNIVERSAL
.25 PRIMERA SECCIÓN Miércoles 06 de Septiembre de 2023
PRIMERA SECCIÓN 18 de Marzo de 2024
El Heraldo de Tuxpan
www.elheraldodetuxpan.com.mx
Jueves 21 de Marz0 de 2024
@Heraldo_Tuxpan
¡SE ACCIDENTA!

Por manejar a exceso de velocidad, motorista pierde el control en una curva y derrapa, en Martínez de la Torre.
¡ENCONTRONAZO!
Una persona muerta y otras más lesionada, deja choque entre dos motocicletas, en Emiliano Zapata. PASE A LA 22

¡DESBARATA SU VEHÍCULO! Conductora de camioneta vuelca y rebota contra árbol, luego de festejar su cumpleaños, en Veracruz. PASE A LA 23

PERCANCE VIAL
PASE A LA 21
Colisionan dos camionetas, ambas salen del camino y una queda con las llantas hacia arriba, en Cotaxtla. PASE A LA 23








 Directora
Directora